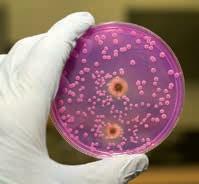

Interruttore di livello capacitivo compatto con indicazione a 360° della condizione d’intervento

Selezionabile individualmente:
256 colori Misura in corso Commutazione del sensore Malfunzionamento nel processo
15 cm
www.vega.com/vegapoint
Calibrazione con smartphone Sistema di adattatori igienici Design compattoLa nostra linea bioavid rileva allergeni alimentari, prevenendo reazioni allergiche nei consumatori. Kit esclusivi per analisi di superfici, campioni d’acqua e alimenti.
Vantaggi: facile individuazione di falsi negativi (hook line) risultati rapidi in 10 minuti, adatto a tutti.
Richiedi un incontro personale (02 9823 3330 - info@r-biopharm.it)
Scopri la RIDA®SMART BOX, unità di imaging per test micotossine quantitativi. Con RIDA®SMART APP, offre flessibilità, compatibilità Android, connettività avanzata e ambiente di misurazione standardizzato.
Richiedi un incontro personale (02 9823 3330 - info@r-biopharm.it)
I kit RT-PCR SureFood® e SureFast® sono progettati per la rilevazione di allergeni, patogeni, OGM e specie animale in materie prime, prodotti finiti e matrici complesse.
Grazie all’estrazione automatica di DNA/RNA e all’utilizzo del termociclatore RIDA®CYCLER, si minimizza l’intervento dell’operatore e si semplifica l’intero processo di analisi, fornendo risultati affidabili e tempestivi.
Richiedi un incontro personale (02 9823 3330 - info@r-biopharm.it)
Utilizza i kit della linea Enzytec™ Liquid per il dosaggio semplice e rapido di zuccheri, acidi organici, alcoli e altri componenti in alimenti, bevande e mangimi. Reagenti liquidi e stabili, adatti per l’automazione, che garantiscono un’elevata precisione e sensibilità.
Supporto tecnico e applicativo.
Richiedi un incontro personale (02 9823 3330 - info@r-biopharm.it)
R-Biopharm Italia Srl
Via Morandi 10 – 20077 Melegnano (MI) – Tel: 02 9823 3330
E-mail: info@r-biopharm.it – www.r-biopharm.com
 LAURA MONGIELLO Presidente Consiglio dell’Ordine Nazionale dei Tecnologi Alimentari
LAURA MONGIELLO Presidente Consiglio dell’Ordine Nazionale dei Tecnologi Alimentari
Si è tenuto a Roma, lo scorso 13 marzo, presso la Sala Capitolare del Senato della Repubblica, il convegno dal titolo “Ricerca e tecnologie per il futuro dell’industria agroalimentare”, organizzato dal Consiglio Nazionale dell’Ordine dei Tecnologi Alimentari (OTAN) e Federalimentare, nell’ambito di un protocollo che ha l’obiettivo di valorizzare la nostra figura professionale all’interno dell’industria alimentare italiana, per guidare le produzioni verso standard di qualità sempre più elevati e rispondenti ai bisogni della società.
Non esiste progresso senza scienza, e la scienza degli alimenti svolge da sempre un ruolo cruciale nell’evolversi della società
Il convegno, moderato dal dott. Giorgio Donegani, Portavoce di OTAN, ha rappresentato un’occasione di confronto tra Istituzioni, Industria e Professionisti, attraverso il quale individuare modalità di rapporto efficaci nell’interesse comune, a tutela della salute della collettività. Un confronto oggi più che mai necessario per costruire, insieme, un nuovo approccio nella gestione della complessità della filiera agroalimentare, nella consapevolezza che non esiste progresso senza scienza, e la scienza degli alimenti svolge da sempre un ruolo cruciale nell’evolversi della società. È riconosciuta da tutti l’importanza dell’alimentazione per il benessere della comunità, ma le urgenze che ci troviamo ad affrontare richiedono di riflettere se, effettivamente, i modelli attuali di produzione e di consumo sono funzionali a una crescita diffusa di questo benessere.
Le sfide che ci attendono sono tante e importanti a cominciare dal dover garantire a tutti l’accesso al cibo sicuro da un punto di vista igienico-sanitario, nutriente e di elevata qualità, nel rispetto dell’ambiente e dei principi etici. In questo senso, la ricerca e le tecnologie agroalimentari diventano uno dei pilastri sui quali costruire risposte efficaci, e su questo percorso si muove l’Ordine dei tecnologi alimentari che vigila sul rispetto di un rigido codice deontologico, e quindi dei principi etici, dei suoi iscritti che quotidianamente lavorano all’interno della filiera agroalimentare.
Nella prima parte del convegno organizzato dal Consiglio Nazionale dell’Ordine dei Tecnologi Alimentari (OTAN) e Federalimentare si è dato spazio agli interventi istituzionali. Presente il capo della segreteria tecnica del MASAF, avv. Sergio Marchi, in rappresentanza del ministro Francesco Lollobrigida, che ha sottolineato l’impegno del ministero nel sostenere le filiere agroalimentari per valorizzare le produzioni italiane.
“Il convegno,” afferma Marchi, “arriva in un momento utile a delineare il quadro di una nuova visione dell’agroalimentare che, come ministero, stiamo portando avanti in tutte le sedi, nazionale, europea e nel contesto internazionale per individuare soluzioni alle complesse dinamiche che stanno attraversando il nostro tempo. Il rafforzamento della pro -
mozione delle eccellenze del Made in Italy, la salvaguardia della produttività e del modello di trasformazione sostenibile sono elementi che devono guidare il sistema Paese in un percorso evolutivo. Ed è proprio la professionalità dei Tecnologi Alimentari, messa a disposizione del sistema, a generare dinamiche innovative e a migliorare i processi produttivi e di consumo che sono in linea con la nostra idea di tutela della sicurezza e sovranità alimentare”.
Anche il Presidente della commissione agricoltura della Camera dei deputati, Mirco Carloni, promotore della legge sull’imprenditoria giovanile in agricoltura, sottolinea l’importanza dei Tecnologi Alimentari nella filiera: “I tecnologi ci consegnano la sicurezza alimentare e danno un’idea chiara della qualità del nostro cibo, contribuendo alla fiducia
che i consumatori hanno nei confronti delle nostre produzioni. Le sfide che ci attendono, tra cui il cambiamento climatico, richiedono l’applicazione delle migliori tecnologie per ridurre l’impatto ambientale delle produzioni”.
Cruciale dunque anche per Carloni l’investimento nelle tecnologie alimentari e nella ricerca, così come sostiene Francesco Battistoni, vicepresidente della Commissione Ambiente, Territorio e Lavori Pubblici della Camera: “I progressi tecnologici come l’agricoltura di precisione, le TEA e l’intelligenza artificiale sono alcuni esempi virtuosi che ci dicono come la ricerca e la scienza, applicate in campo alimentare, possano contribuire a rendere l’industria alimentare sempre più un luogo sicuro per i cittadini che ne riconoscono affidabilità, qualità e fiducia”.
CHE IL CIBO SIA LA BASE PRINCIPALE DEL PROPRIO BENESSERE
Entrando nel vivo delle relazioni scientifiche si è tracciato un quadro chiaro sul valore dell’industria alimentare partendo proprio da una ricerca effettuata dal Censis e presentata dal prof. Giorgio De Rita, segretario generale, analizzando il rapporto tra il valore economico e quello sociale dell’industria alimentare italiana. Negli ultimi dieci anni è aumentato l’export del 60%, l’occupazione del 12% e il fatturato del 25%, in un contesto in cui i consumi e i salari sono fermi e sarebbe stato facile seguire la linea della decrescita felice. “La base sociale che ha permesso questi risultati,” afferma il Prof. De Rita, “è che l’industria ha svolto un ruolo di ammortizzatore sociale, di assicurazione nei confronti delle famiglie, di welfare, fornendo garanzia agli italiani che l’industria poteva meritare fiducia”.
Secondo il rapporto del Censis, il 91% degli Italiani ritiene che il cibo sia la base principale del proprio benessere. “Oltre alle evidenze scientifiche,” afferma De Rita, “c’è dunque la consapevolezza che la produzione alimentare italiana è una delle principali fonti del benessere individuale”. Lo studio, inoltre, evidenzia che per gli italiani sono importanti i valori etici e sociali che li orientano nella scelta dei prodotti. Il 66,7% è pronto a rinunciare a prodotti che potrebbero essere dannosi per la salute, il 52,6% a quelli non in linea con criteri di sicurezza alimentare, il 43,3% a quelli la cui produzione e distribuzione non rispetta l’ambiente e il 35,6% a quelli per la cui produzione non sono tutelati i diritti dei lavoratori e dei fornitori. Accanto a questi numeri, emerge inoltre come l’industria alimentare abbia una elevata reputazione sociale verso la quale l’86,4%
degli italiani dichiara di avere fiducia ed è una fiducia trasversale, che coinvolge il 93,8% degli anziani, l’84,2% degli adulti e l’81,6% dei più giovani. Tutto ciò certifica come, grazie alla ricerca, alla scienza e alla tecnologia gli alimenti e l’industria di trasformazione abbiano prodotto una rivoluzione positiva nelle abitudini e nelle scelte degli italiani che ricercano cibi sicuri e di qualità. “Quello che emerge è dunque un quadro di fiducia che contrasta con la percezione diffusa di un’industria che si contrappone a un modo “bucolico” di produrre gli alimenti che non esiste”, afferma Donegani. Viene fuori dunque la resilienza dell’industria alimentare che ha avuto il merito di adattarsi all’attuale contesto storico, particolarmente difficile, individuando soluzioni e risposte efficaci e compiendo lo sforzo di comunicarle per contrastare la disinformazione che colpisce il settore del food. Importante è dunque sottolineare quella che è stata l’evoluzione della ricerca e delle tecnologie nel settore agroalimentare con un occhio al passato proprio per comprendere il presente e ipotizzare il futuro.
Il prof. Marco Dalla Rosa, dell’Università di Bologna, ha infatti tracciato un excursus storico. Nel corso dei secoli la capacità primaria dell’essere umano è sempre stata quella di procacciarsi cibo e di utilizzare tecniche sempre più avanzate per garantirne la conservazione. L’evoluzione storica e culturale di questa necessità, facilitata dalle scoperte delle scienze microbiologiche, chimiche, fisiche, ingegneristiche e meccaniche, ha portato alla nascita della Food Science ovvero la Scienza e Tecnologia degli Alimenti. Gli obiettivi principali di questa scienza applicata alla lavorazione tecnologica degli alimenti sono stati quelli di rendere ottimali i processi produttivi, di garantire la salubrità degli alimenti, di garantire il massimo apporto nutrizionale, di migliorare la qualità sensoriale e di allun-
gare la vita commerciale dei prodotti destinati ai consumatori. Questo progresso ha permesso, e permette, di fornire prodotti sicuri e nutrienti alla popolazione, adeguandosi nel tempo alle sempre nuove necessità dettate dall’evoluzione della società e dalle problematiche che si trova ad affrontare.
Per ottenere prodotti alimentari di qualità occorre partire da materie prime di qualità. Di qui l’importanza della sinergia professionale tra Tecnologi Alimentari e Agronomi e l’applicazione, anche in agricoltura, di tecnologie avanzate. Questo il focus dell’intervento di Flavio Pozzoli, Presidente dell’Ordine degli agronomi e dottori forestali di Roma: “La rintracciabilità della filiera alimentare può essere fortemente supportata dalla tecnologia della blockchain già a partire dalle attività in campo. Per questo si parla sempre più spesso di agricoltura di precisione o digitale proprio perché le soluzioni innovative nel settore agricolo stanno trasformando il modo in cui vengono coltivati i prodotti agricoli e le modalità di gestione degli allevamenti. Avere a disposizione dati precisi e in tempo reale permette di agire in modo tempestivo sui sistemi agricoli riducendo gli sprechi e prevenendo il diffondersi di fitopatie a carico dei campi coltivati. Prevenire gli sprechi è senza dubbio un’azione necessaria in un contesto in cui non è garantito a tutti un accesso al cibo sicuro e sufficiente per il raggiungimento del benessere individuale. Infatti, nel 2022, il 29,6% della popolazione mondiale, pari a 2,4 miliardi di persone, non ha avuto accesso costante al cibo. Le sfide che ci attendono sono molto complesse: garantire un elevato livello di sicurezza alimentare attraverso misure coerenti ‘Dal produttore al consumatore’ e fornire alimenti equilibrati nell’apporto di energia e/o nutrienti per consentire la completa espressione
del potenziale genetico, fisico e mentale dell’individuo, per una aspettativa di vita sana (priva di malattie)”.
“Innanzitutto,” afferma Stefano Zardetto, Presidente dell’Ordine dei Tecnologi Alimentari di Veneto e Trentino Alto Adige, “occorre raggiungere la piena sostenibilità del sistema agroalimentare, e un processo alimentare è davvero sostenibile se limita il consumo di risorse e la produzione di rifiuti, contribuisce positivamente a soddisfare le attuali esigenze alimentari, risulta socialmente equo e inclusivo, mantenendo la sicurezza igienico-sanitaria e la qualità nutrizionale del prodotto e provvede a fornire un gettito economico costante per le imprese. Serve una ricerca scientifica a 360 gradi senza pregiudizi e stereotipi, con un approccio multi-attore in grado di produrre benefici congiunti per la salute delle persone, il clima, il pianeta e le comunità. Il Tecnologo Alimentare è dunque impegnato nel miglioramento dei processi e nello sviluppo di tecnologie d’avanguardia, aprendo la strada a nuovi prodotti e metodologie di produzione”. “È essenziale,” conclude Zardetto, “dare un contributo al futuro del pianeta andando oltre il convenzionale anche attraverso il cibo”. Sfida raccolta, nell’ambito del convegno, dal vicepresidente del Senato, sen. Gian Marco Centinaio, che sottolinea come l’impegno degli operatori del settore alimentare e dei professionisti che applicano la ricerca e le tecnologie alimentari consentono alle produzioni italiane di distinguersi per l’eccellente qualità nel panorama internazionale. L’Italia ha dunque il dovere di dettare la linea a livello mondiale, come nel caso della questione dell’etichettatura a semaforo bloccata grazie all’autorevolezza dei nostri connazionali. Il sistema Italia è fatto soprattutto da una cultura che unisce, che ha come

denominatore comune il valore del Made in Italy, che trova il supporto delle Istituzioni politiche e che in una logica di continuità dei valori condivisi riesce a essere di sostegno alle industrie, ai professionisti, che lavorano quotidianamente per garantire l’eccellenza delle nostre produzioni. Anche il ministro delle imprese e del made in Italy, Adolfo Urso, ha partecipato al dibattito con un suo messaggio in cui sottolinea la necessità di sostenere investimenti per nuovi modelli produttivi.
A conclusione dei lavori, Paolo Mascarino, sottolinea la forza dell’Industria Alimentare italiana, che, con quasi 200 miliardi di fatturato nel 2023 e 52 miliardi di export, rappresenta, insieme al settore primario, la prima manifattura del paese e il 10% dell’export dell’Italia.
“Forza,” sostiene Mascarino, “che si basa su quattro pilastri: il genio italiano, capace di trasformare materie prime di qualità in prodotti unici e inimitabili, genio che si estrinseca con due braccia: la tecnologia e l’arte; di qui il grande valore dei Tecnologi Alimentari che danno ai processi di tra-
sformazione a cui gli imprenditori aggiungono l’arte per rendere i prodotti unici al mondo; il secondo è fare squadra, collaborare tutti insieme per far si che il settore alimentare mantenga il suo primato di eccellenza; il terzo è quello di continuare a innovare con i piedi saldi nella tradizione della dieta mediterranea, il quarto e ultimo pilastro sono i consumatori italiani che hanno un gusto straordinario, sono molto esigenti e questo obbliga imprenditori a fare i miracoli per rispondere alla sofisticata domanda dei consumatori italiani”. Questa narrativa si scontra con una narrativa opposta a livello internazionale, infatti, nel 2025 ci sarà il meeting sulle malattie trasmissibile in cui L’ONU proverà a far applicare all’alimentare le norme che valgono per il tabacco, classificando i cibi in sani e non sani attraverso algoritmi che hanno poco di scientifico e che darebbero il rosso a prodotti italiani di qualità quali olio di oliva e parmigiano reggiano. “Occorre dunque rafforzare la squadra,” conclude Mascarino, “facendo leva su un solido sostegno delle istituzioni, della comunità scientifica e dei tecnologi alimentari per affrontare insieme questa nuova battaglia a tutela della salute pubblica”.



Direttore Responsabile Giorgio Albonetti
Direttore Scientifico
Massimo Artorige Giubilesi
Comitato tecnico scientifico
Giancarlo Belluzzi, Vincenzo Bozzetti, Francesco Fiorente, Gaetano Forte, Luciano Negri, Erasmo Neviani, Serena Pironi, Daniele Roseghini
Coordinamento editoriale
Chiara Scelsi c.scelsi@lswr.it Cel. 3490099322
Redazione Diletta Gaggia d.gaggia@lswr.it redazione.food@quine.it
50
Produzione
Antonio Iovene a.iovene@lswr.it Cel. 3491811231
Direttore Commerciale
Costantino Cialfi c.cialfi@lswr.it tel. 3466705086
Traffico
Ornella Foletti ornella.foletti@quine.it Cel. 3427968897
ABBONAMENTI
www.quine.it
abbonamenti.quine@lswr.it Tel. 02 864105
www.alimentinews.it
Costo copia singola: € 2,80
Abbonamento annuale Italia: € 40
Stampa
Aziende Grafiche Printing Srl Peschiera Borromeo (MI)
Quine Srl
Produzione & Igiene Alimenti - Bimestrale
Rivista ufficiale del Consiglio dell’Ordine Nazionale dei Tecnologi Alimentari
Autorizzazione del Tribunale di Milano n. 510 del 29-10-1983
Iscrizione al ROC n. 23531 dal 6 Maggio 2013
Tutti gli articoli pubblicati su Produzione & Igiene Alimenti sono redatti sotto la responsabilità degli Autori. La pubblicazione o la ristampa degli articoli deve essere autorizzata per iscritto dall’Editore. Ai sensi dell’art. 13 del Regolamento Europeo per la Protezione dei Dati Personali 679/2016 di seguito GDPR, i dati di tutti i lettori saranno trattati sia manualmente, sia con strumenti informatici e saranno utilizzati per l’invio di questa e di altre pubblicazioni e di materiale informativo e promozionale. Le modalità di trattamento saranno conformi a quanto previsto dal GDPR. I dati potranno essere comunicati a soggetti con i quali Quine Srl intrattiene rapporti contrattuali necessari per l’invio delle copie della rivista. Il titolare del trattamento dei dati è Quine Srl, Via Spadolini 7 - 20141, Milano, al quale il lettore si potrà rivolgere per chiedere l’aggiornamento, l’integrazione, la cancellazione e ogni altra operazione di cui all’art. 7 D.Lgs. 196/03.

MASSIMO ARTORIGE GIUBILESI
Presidente Ordine dei Tecnologi Alimentari Lombardia e Liguria
Il nuovo volto della tecnologia alimentare
Nel corso degli ultimi decenni, la professione del Tecnologo Alimentare (TA per sintesi) ha compiuto un viaggio che definirei straordinario, evolvendosi da un focus tradizionale sulla produzione e conservazione degli alimenti a un ruolo centrale nell’innovazione tecnologica, nello sviluppo dei processi e nella sostenibilità dell’intera filiera (produzione, trasformazione, distribuzione, ristorazione).
Questo percorso ha visto i professionisti del settore adattarsi a sfide in continua evoluzione, dalla sicurezza alimentare all’ottimizzazione della catena di approvvigionamento, fino all’applicazione di tecnologie rivoluzionari e alla promozione di pratiche sostenibili.
La capacità di anticipare le tendenze future, di adattarsi alle nuove tecnologie e di incorporare principi di sostenibilità in ogni aspetto del lavoro diventa essenziale
Anche se ci sembra passato un secolo, basta ricordare come negli Anni ’80-90 la nostra attenzione era focalizzata proprio sulla qualità e sulla sicurezza alimentare che, a causa della nascente globalizzazione dei mercati, chiedevano una risposta più puntuale a livello di sistemi di gestione e di controlli per garantire standard più elevati su scala internazionale.
Come TA abbiamo lavorato, grazie alle nostre competenze multidisciplinari, intensamente allo sviluppo di metodi per prolungare la conservazione degli alimenti, migliorarne la qualità e garantire la sicurezza per i consumatori, in primis con l’applicazione del Sistema HACCP (Hazard Analysis and Critical Control Points).
Con l’avvento, alla fine del XX secolo, della biotecnologia e degli studi genomici, la professione del TA ha iniziato a occuparsi di tecniche avanzate con lo scopo di migliorare la resistenza delle
colture, aumentare i rendimenti e produrre alimenti con caratteristiche nutrizionali migliorate. Questo periodo ha segnato l’inizio dell’era della “food science” che si è spinta nel cuore molecolare degli alimenti e ha aperto in questo modo un nuovo capitolo nella storia della produzione alimentare.
Con l’arrivo del nuovo millennio, la crescente consapevolezza dei consumatori sugli impatti della dieta (dal greco dìaita regime, stile, tenore di vita, quindi alimentazione corretta, sana ed equilibrata) e sulla salute ha comportato un cambiamento significativo.
I TA hanno iniziato a concentrarsi maggiormente sullo sviluppo di prodotti che fossero non solo sicuri e durevoli, ma anche benèfici per la salute anche sotto il profilo nutrizionale, supportando la ricerca e sviluppo di nuovi prodotti con minor contenuto di grassi, zuccheri e sale, ovvero di alimenti arricchiti e funzionali, progettati per fornire benefìci aggiuntivi oltre alla nutrizione di base.
Negli ultimi anni, l’avvento dell’era digitale e l’aumento della preoccupazione per la sostenibilità hanno portato a una nuova ondata di innovazioni nel settore alimentare.
La digitalizzazione ha introdotto strumenti avanzati per la tracciabilità della filiera, la gestione della qualità e l’ottimizzazione dei processi produttivi, consentendo ai TA di lavorare con maggiore precisione ed efficienza.
La sostenibilità è diventata un pilastro fondamentale, con un focus crescente sullo sviluppo di pratiche di produzione più ecologiche, sulla riduzione degli sprechi alimentari e sull’innovazione in ambito di packaging sostenibile. Oggi, la professione del TA si sta orientando sempre più verso l’innovazione e la personalizzazione, con l’obiettivo di soddisfare le esigenze specifiche di diversi gruppi di consumatori. Ciò include lo sviluppo di alternative vegetali alle proteine animali, alimenti personalizzati basati su genetica e microbioma individuale e l’utilizzo della IA (Intelligenza Artificiale) per prevedere le tendenze di consumo e ottimizzare le formulazioni dei prodotti.
Tuttavia, il viaggio è lungi dall’essere concluso. Le accelerazioni senza precedenti del progres-
so tecnologico e l’urgente necessità di soluzioni sostenibili per il nostro sistema alimentare globale, richiedono ai TA di essere ancora più agili, informati, innovativi.
La capacità di anticipare le tendenze future, di adattarsi rapidamente alle nuove tecnologie e di incorporare principi di sostenibilità in ogni aspetto del lavoro non è più facoltativa, ma essenziale.
Non voglio dunque parlare delle solite “sfide del futuro” ai quali la nostra professione deve rispondere. Penso invece che sia giunta l’ora di diventare coscienti e consapevoli che, in questo contesto alquanto dinamico e impegnativo, la nostra professione si trova di fronte alla necessità imperativa di sviluppare nuove competenze. Oltre la conoscenza tecnica tradizionale, abbracciando la capacità di pensare in modo critico, di lavorare in modo interdisciplinare e di comunicare efficacemente con un pubblico trasversale.
Per tutti noi TA diventa fondamentale riuscire a dare la massima priorità e urgenza al bisogno di rinnovare l’approccio nel campo della tecnologia alimentare, puntando decisamente verso l’integrazione digitale. Questo cambiamento non si limita solamente all’adozione di nuovi strumenti tecnologici, ma implica una trasformazione culturale profonda nel nostro modo di pensare e operare da professionisti moderni.
Un vero e proprio adattamento darwiniano che testimonia come “la specie che sopravvive è quella che risponde meglio al cambiamento”, facendo prevalere i soggetti “che hanno imparato a collaborare e a improvvisare con più efficacia”. L’incorporazione dell’intelligenza artificiale nei vari livelli della filiera alimentare segna l’inizio di un’era in cui decisioni le decisioni e le pratiche sostenibili sono destinate a diventare la norma, non l’eccezione. Questo passaggio verso una maggiore digitalizzazione e largo utilizzo di IA sarà il passo fondamentale da compiere per tutti noi verso il futuro, unendo tecnologia avanzata e sostenibilità per creare un sistema alimentare che sia resiliente, efficiente e attento alle necessità del nostro pianeta e del nostro mondo in continuo mutamento.

BENEDETTA BOTTARI
Professore Associato Microbiologia degli Alimenti Università degli Studi di Parma
ESSERE O NON ESSERE CAPACI DI SCEGLIERE E FAR SCEGLIERE UN PRODOTTO CON O SENZA DENOMINAZIONE
LPeculiari caratteristiche qualitative dal territorio in cui gli alimenti sono stati prodotti dipendono essenzialmente o esclusivamente
a denominazione di origine protetta, DOP, è un marchio di tutela giuridica della denominazione che viene attribuito dall’Unione Europea agli alimenti le cui peculiari caratteristiche qualitative dipendono essenzialmente o esclusivamente dal territorio in cui sono stati prodotti. Del territorio fanno parte elementi associati all’ambiente ma anche a chi opera all’interno di esso, attraverso conoscenze, modalità e tecniche che plasmano un prodotto intimamente associato al luogo da cui proviene, rendendolo distinto, e teoricamente riconoscibile, da ogni sua possibile imitazione, prodotta all’infuori dell’area geografica della denominazione. È su questa teorica possibilità di distinzione tra un prodotto DOP e un suo simile non DOP, che spesso si sono giocate interminabili battaglie legali o campagne di marketing più o meno lecite. Ma cosa guida il consumatore verso la scelta di acquistare un prodotto DOP o non DOP? Qual è il grado di conoscenza delle caratteristiche intrinseche (com’è fatto, che sapore ha) ed estrinseche (il marchio, il prezzo, le informazioni in etichetta etc.) dell’alimento, con cui il consumatore si appresta a fare la sua spesa? Per alcune tipologie di prodotti, come il vino e i formaggi, il legame con il territorio è forte per la materia prima, che però viene significativamente trasformata dall’attività metabolica dei microrganismi fermentativi. Per un formaggio a latte crudo, prodotto con innesto naturale, il patrimonio microbico del latte insieme a quello dello starter rappresentano un ulteriore importantissimo e indissolubile legame con l’ambiente d’origine e di lavorazione e, soprattutto in caso di stagionatura, sono in gran parte responsabili delle caratteristiche qualitative specifiche di ogni formaggio. Correlare in modo oggettivo e misurabile tali caratteristiche ai microrganismi che le hanno generate, ed eventualmente alle preferenze espresse dal consumatore, potrebbe consentire di introdurre un nuovo elemento di scelta verso l’acquisto di un prodotto DOP o non DOP. L’idea è alla base di un progetto di ricerca finanziato con fondi PRIN (Progetti di ricerca di rilevante interesse nazionale) che vede coinvolte l’Università di Parma, come coordinatore, l’Università di Torino e l’Università di Bari (https://pdononpdocheeses.it/it/) nell’integrazione di analisi multi-omiche su diversi formaggi con studi di consumer science. Se i risultati confermeranno le ipotesi fatte, questo tipo di approccio permetterà a tutti gli attori di una filiera produttiva come quella del formaggio, ma non solo, di fornire gli strumenti di comunicazione utili per una maggiore valorizzazione dei prodotti DOP e non DOP.


MAXventowlet – il ventilatore ideale per macchine e impianti di produzione, trasformazione e conservazione di prodotti agro-alimentari. La serie Maxventowlet ad alte prestazioni adatta alle medie-alte pressioni è la più indicata per la conservazione degli alimenti anche durante il loro processo di trasformazione.
MAXventowlet garantisce uniformità in termini di temperatura e umidità in tutti gli ambienti dove gli alimenti sostano o vengono trasformati o semplicemente conservati in attesa di essere distribuiti al Retail. www. ziehl-abegg.it




Vantaggi
▪ facile e sicura igienizzazione
▪ utilizzo in ambienti con temperature estreme: da – 60° C +120°C
▪ prodotto customizzabile per i più esigenti settori di applicazione
▪ grande comfort acustico dell’ambiente lavorativo
In Italia ci sono 46.818 imprese attive nella produzione (esattamente 35.253, ossia il 76% del totale) e nel commercio (11.565, pari al 24%) di prodotti di panificazione, pizza e pasticceria. A fornire questi numeri l’AIBI - Associazione Italiana Bakery Ingredients, in occasione di Sigep a Rimini.
Nel 2023, il valore complessivo della produzione dell’intero comparto è stato di 13,4 miliardi di euro, il 67% del quale prodotto da realtà con oltre 10 addetti, che costituiscono solo l’8,2% del totale imprese. Per il 2024 le previsioni sono positive: le imprese del commercio di pane, pizza e pasticceria prevedono una crescita media dei consumi pari all’1,6%. Rispetto ai consumi, le abitudini degli italiani stanno cambiando e tendono a dare sempre più attenzione alla ricerca di un prodotto di qualità. Secondo l’indagine,

il 54,4% chiede che il prodotto sia digeribile e il 31,2% lo preferisce di tipo salutistico, in risposta a intolleranze o a specifiche esigenze dietetiche o intolleranze. Per il 66,4% dei consumatori è fondamentale la scelta degli ingredienti, anche per la pasticceria: le farine tradizionali prevalgono (sono scelte dal 66,6% degli artigia-
Un’indagine sulle imprese agricole e alimentari condotta da Nomisma fa luce sulla transizione ecologica in atto nel settore, tra investimenti per le energie rinnovabili, digitalizzazione a supporto della produzione, semplificazione della burocrazia.
Dallo studio emerge come le imprese italiane abbiano un’elevata consapevolezza sul fatto che la produzione di energia rinnovabile sia oggi una delle leve principali per raggiungere la sostenibilità. Il gap da colmare per raggiungere l’obiettivo del 42,5% di quota di energia rinnovabile entro il 2030 è ancora ampio. In Italia siamo al 19%, contro una media UE del 23% e lontanissimi dall’eccellenza svedese, che guida il ranking continentale con il 66%. Gli strumenti tecnologici e digitali vengono considerati fondamentali per rendere la propria impresa non solo più performante, ma anche più sostenibile. Il 32% delle
ni), cresce l’impiego di quelle alternative come riso, soia e manitoba che, nel 2024, potrebbero rappresentare più del 20% del mercato. Tra i grassi domina invece il burro, ma il 16% degli artigiani apprezza la nuova margarina, a base vegetale e ripensata per chi ha problemi dietetici o di intolleranze.

aziende agricole intervistate ha dichiarato di utilizzare macchine con guida assistita o semi-automatica con GPS integrato, un 25% di avere centraline meteo aziendali. Per migliorare la diffusione di strumenti innovativi servono però alcuni cambiamenti strutturali: secondo le imprese devono
principalmente riguardare la riduzione della burocrazia (per 6 intervistati su 10), il miglioramento della politica energetica (nel 33% dei casi), gli investimenti nelle infrastrutture ambientali (25%) e la promozione dello sviluppo di progetti con fondi pubblici (23%). (
Fonte: ANSA)
È stata raggiunta a livello comunitario un’intesa tra le istituzioni europee (il Consiglio UE e il parlamento europeo) sul regolamento sugli imballaggi in linea con l’obiettivo di raggiungere un calo dei rifiuti da imballaggio del 5% entro il 2030, del 10% nel 2035 e del 15% entro il 2040, come previsto nella proposta iniziale della Commissione europea.
Saranno quindi vietati dal 2030 alcuni formati di imballaggi in plastica monouso, come gli imballaggi per frutta e verdura fresca non trasformata, imballaggi per alimenti e bevande riempiti e consumati in bar e ristoranti, porzioni individuali (come condimenti, salse, panna, zucchero), e prodotti in miniatura per i prodotti da toilette negli alberghi. Le nuove norme prevedono anche restrizioni sul contenuto di Pfas – le sostanze perfluoroalchiliche – sugli imballaggi a contatto con gli alimenti.

Sono state stabilite anche nuove limitazioni allo spazio vuoto degli imballi per indurre un confezionamento raggruppato con un rapporto massimo di spazio vuoto fissato del 50% per il trasporto e il commercio elettronico. Nuovi obblighi anche per le imprese di asporto che dovranno offrire ai clienti la possibilità di portare con sé i propri contenitori da riempire con bevande fredde o calde o cibi pronti, senza costi aggiuntivi. Salvi due comparti molto importanti per l’Italia, l’imballaggio di vino e il florovivaismo.
“Questo regolamento mira a ridurre i rifiuti causati dagli imballaggi, rendendoli più sostenibili, garantendo al contempo i più elevati standard di gestione dei rifiuti”, la dichiarazione della Presidenza UE. Sono state accolte parzialmente le richieste fatte dall’Italia che aveva chiesto ad esempio alcune deroghe. Nonostante questo, i divieti su alcuni imballaggi monouso continuano a essere considerati insoddisfacenti per il nostro governo e per le principali associazioni di categoria. Per la filiera agroalimentare italiana rappresentata da Coldiretti, Filiera Italia, Cia, Confapi, Ancc-Coop, Ancd-Conad, Legacoop, Legacoop Agroalimentare, Legacoop Produzione&Servizi, Coop, Flai Cgil, Fai-Cisl e Uila-Uil, il testo può essere ancora migliorato. Le associazioni hanno rilasciato una nota congiunta in cui auspicano che “nel negoziato in corso ci possano essere ulteriori scelte a difesa delle imprese europee che evitino l’inquinamento e lo spreco alimentare, come avverrebbe con alcune proposte ora sul tavolo che non tutelano a sufficienza alcuni settori quali l’ortofrutta”.
Il regolamento comunque non sarà inderogabile: sarà infatti rivalutato tre anni dopo l’entrata in vigore sulla base dello stato di sviluppo tecnologico degli imballaggi in plastica a base biologica. Sarà per questo che verranno poi stabiliti requisiti di sostenibilità per gli imballaggi in bioplastica.
Prendere le decisioni giuste – questa è la cosa più importante per ogni azienda alimentare. Report dettagliati, dati attuali dalla produzione, andamento degli ordini: il CSB-System vi fornisce esattamente questa trasparenza, semplicemente premendo un tasto. Così anche in tempi incerti potrete prendere decisioni certe.
Per saperne di più sulle nostre soluzioni per il settore alimentare: www.csb.com

a cura della Redazione
DOI: 10.1016/j.lwt.2023.115218
Strategie di chiarifica per la prevenzione dei depositi di quercetina nei vini Sangiovese
Fining strategies for quercetin deposit prevention in sangiovese wines. LWT, Volume 185, 1 agosto 2023
L. Picariello, A. Rinaldi, L. Moio, V. Moine, A. Gambuti
La quercetina è un composto fenolico appartenente alla classe dei flavonoli, presente nelle piante, tra cui gli acini d’uva, anche in forme glicosidiche. Negli ultimi anni, i cambiamenti climatici e le radiazioni UVB favoriscono la biosintesi della quercetina nell’uva, aumentando il rischio di formazione e precipitazione di cristalli di questo composto nei vini rossi. La precipitazione di quercetina nei vini imbottigliati determina un deprezzamento da parte dei consumatori con grandi perdite economiche per i produttori di
vino. Nello studio è stata applicata una strategia volta a ridurre il contenuto di quercetina (Q) e di glicosidi della quercetina (QG) per prevenire future precipitazioni di questo composto nei vini. Sono stati testati diversi agenti chiarificanti enologici: polivinilpolipirrolidone (PVPP), una proteina vegetale (VP), quattro lieviti lisati (YLs) e un prodotto polifunzionale (MIX) ottenuto miscelando PVPP, proteine vegetali e un lievito lisato selezionato tra i quattro testati. Per ciascun chiarificante sono state ottenute le isoterme di adsorbimento; sulla base del modello di Freundlich, PVPP e MIX hanno mostrato il miglior assorbimento di Q e QG. Il MIX ha determinato anche un contemporaneo minor assorbimento degli altri composti fenolici. Il trattamento effettuato con MIX sui vini Sangiovese ha determinato una diminuzione di quercetina (da -27 a -47% rispetto ai valori iniziali) e di glicosidi della quercetina (-17%) preservando gli antociani del vino.


DOI: 10.3168/jds.2022-22968
Disponibilità dei consumatori a pagare per la durata di conservazione del latte pastorizzato ad alta temperatura e in breve tempo: implicazioni per l’etichettatura intelligente e la riduzione degli sprechi alimentari
Consumer willingness to pay for shelf life of high-temperature, short-time-pasteurized fluid milk: Implications for smart labeling and food waste reduction. Journal of Dairy Science, Volume 106, numero 9, settembre 2023, pagine 5940-5957
P. Endara, M. Wiedmann, A. AdaljaNel 2019 negli Stati Uniti lo spreco alimentare è stato valutato a 285 miliardi di dollari, pari al 70% delle eccedenze alimentari; i soli latticini e uova rappresentavano il 15,90%. Il latte è la quinta bevanda più consumata negli Stati Uniti e quindi il suo contributo allo spreco alimentare ha significative implicazioni economiche e ambientali. Etichette intelligenti che forniscono informazioni precise sul deteriora-

mento del latte possono aiutare a ridurre gli sprechi alimentari, ma non è chiaro se i consumatori accetteranno o pagheranno per questa nuova tecnologia. Questo articolo esamina le preferenze dei consumatori riguardo al latte pastorizzato ad alta temperatura, con una breve durata di conservazione e alle etichette con data intelligente e verifica come le informazioni sull’impatto ambientale dei rifiuti alimentari a base di latte influiscono sull’accettazione e sulla disponibilità a pagare dei consumatori. I risultati suggeriscono che la valutazione dei consumatori riguardo alla durata di conservazione prolungata e al marchio di qualità ecologica è positiva; tuttavia, l’utilizzo dell’etichetta intelligente crea disutilità per i consumatori, ostacolando così l’accettazione di una nuova tecnologia di etichettatura che potrebbe portare alla riduzione degli sprechi alimentari nell’industria del latte. Questi risultati indicano che i rivenditori dovrebbero trovare mezzi alternativi per migliorare la comunicazione di informazioni precise sulla durata di conservazione e il suo ruolo nella riduzione degli sprechi alimentari.
DOI: 10.1016/j.jfoodeng.2023.111521
Lavorazione ad alta pressione: effetto sulle proprietà strutturali degli alimenti. Una revisione
High-pressure processing: Effect on textural properties of food. A review. Journal of Food Engineering, Volume 351, agosto 2023 K. Gokul Nath, R. Pandiselvam, CK. Sunil
Le crescenti tendenze dei consumatori verso alimenti sicuri con lavorazione zero o minima hanno stimolato l’utilizzo di tecnologie di trattamento non termico. L’adattamento delle metodologie di pretrattamento e lavorazione non termiche si è dimostrato molto efficace nel prolungare la durata di conservazione e nel migliorare la qualità e la sicurezza del prodotto. Il trattamento ad alta pressione (HPP) è un metodo di lavorazione non termico e privo di residui chimici, che prevede l’ap-
plicazione di un’elevata pressione per ottenere alimenti stabili a scaffale, mediante inattivazione microbica ed enzimatica con un impatto minimo sulla composizione nutrizionale e chimica del prodotto. Gli alimenti utilizzati per l’HPP sono carne e prodotti a base di carne, frutta e verdura, latticini, noci e semi, uova e altri prodotti altamente deperibili o minimamente trasformati. L’uso delle alte pressioni sugli alimenti può alterare in modo critico le proprietà strutturali come fermezza, durezza, coesione e altre. La consistenza è una proprietà organolettica molto importante, che può influire sull’accettazione degli alimenti da parte del consumatore. L’HPP ha dimostrato di migliorare gli attributi strutturali di vari prodotti alimentari con un deterioramento minimo. Questa recensione discute criticamente l’impatto dell’HPP sui cambiamenti strutturali nelle diverse matrici alimentari.



DOI: 10.1016/j.foodchem.2023.136524
Degradazione dell’amido nella pasta indotta dall’estrusione al di sotto della temperatura di gelatinizzazione Degradation of starch in pasta induced by extrusion below gelatinization temperature. Food Chemistry Volume 426, 15 novembre 2023
B. Jia, L. Devkota, M. Sissons, S. Dhital
La deformazione strutturale dell’amido durante l’estrusione incide sulla qualità della pasta. I ricercatori hanno studiato l’impatto della forza di taglio sulla struttura dell’amido della pasta e della sua qualità variando la velocità della vite (100, 300, 500 e 600 giri/min) con un intervallo di temperatura compreso tra 25 e 500C con incrementi di 50C, dalla zona di alimentazione alla zona di uscita. Le velocità più elevate delle viti erano associate a un input di energia mec-
DOI: 10.1016/j.fbio.2023.102858
Valutazione della rete proteica e delle caratteristiche sensoriali della pasta fresca di grano duro arricchita con brattee di carciofo e polveri di pomodoro
Protein network assessment and sensory characteristics of durum wheat fresh pasta fortified with artichoke bracts and tomato powders. Food Bioscience, volume 54, agosto 2023
B. La Gatta, M. Rutigliano, F. Dilucia, MT. Liberatore, R. Viscecchia, F. Bimbo, A. Di Lucia
In questo lavoro sono stati studiati campioni di pasta fresca arricchiti con brattee di carciofo e polveri di pomodoro (aggiunte in poltiglia trattata (TM) e polvere di lio (LP) ottenuti attraverso l’applicazione di una tecnologia fisica innovativa, non termica e non invasiva (Brevetto n°001426984 ). I
canica più specifico (157, 319, 440 e 531 kJ/kg per la pasta prodotta a 100, 300, 500 e 600 giri al minuto, rispettivamente), con conseguente viscosità di impasto inferiore (1084, 813 , 522 e 480 mPa·s per pasta prodotta rispettivamente a 100, 300, 500 e 600 giri al minuto) nella pasta a causa della perdita dell’ordine molecolare dell’amido e della cristallinità. La cromatografia di esclusione dimensionale ha rivelato che la pasta prodotta a una velocità delle viti di 600 giri al minuto aveva una distribuzione dimensionale dell’amilopectina inferiore, che indicava la rottura molecolare durante l’estrusione. La pasta prodotta a 600 giri aveva valori più alti di idrolisi in vitro dell’amido (sia crudo che cotto) rispetto alla pasta realizzata a 100 giri al minuto. La ricerca fornisce una relazione su come la velocità delle viti può essere manipolata per progettare pasta con consistenza e funzionalità nutritive diverse.
risultati dei campioni di pasta cruda e cotta hanno indicato come l’aggiunta delle brattee di carciofo abbia avuto una notevole influenza sulla disposizione della rete glutinica rispetto al pomodoro, per entrambe le formulazioni testate, anche se le proprietà tecnologiche sono risultate buone, se confrontate con il campione controllo (pasta di semola 100%). Le analisi chimiche e SDS-PAGE hanno permesso di confermare questi risultati, evidenziando la minore perdita proteica in cottura dei campioni di pasta arricchita con pomodoro, per entrambe le formulazioni testate, grazie a un reticolo proteico del glutine caratterizzato da un’elevata percentuale di proteine polimeriche totali inestraibili (%UPP) e da un elevato rapporto (SS/SH). L’aggiunta delle verdure ha influenzato anche le caratteristiche sensoriali dei campioni, evidenziando come l’aggiunta degli LP abbia condizionato maggiormente l’accettabilità da parte del consumatore.



 IMaria Manuela Russo Vicepresidente OTAN
IMaria Manuela Russo Vicepresidente OTAN
l recente rapporto della FAO 2023
“The Status of Women in agrifood system”, il primo di questo genere da oltre 10 anni, attesta che negli ultimi anni è la donna ad assumersi progressivamente il compito di prendersi cura del pianeta Terra e della terra come risorsa suolo. Analizzando la condizione femminile in tutta la filiera, il settore agroalimentare rappresenta a livello mondiale una tra le principali fonti di impiego (36%), con una percentuale molto ravvicinata a quella degli uomini (38%). Si potrebbe dunque pensare che l’agricoltura, per le donne, sia uno strumento diretto di empowerment, ovvero di consolidamento del loro potere di scelta, dell’incremento delle loro responsabilità e possibilità, e dello sviluppo delle loro conoscenze e competenze. Ma purtroppo non è così: di fatto i ruoli delle donne tendono a essere considerati marginali.
Nonostante il divario di impiego di 2 punti percentuali, i ruoli delle donne tendono a
essere considerati marginali e le loro condizioni lavorative sono peggiori rispetto a quelle degli uomini. Le donne, cioè, tendono ad avere un impiego irregolare, informale, a tempo parziale, poco qualificato o ad alta intensità di lavoro. Anche sul piano dei salari all’interno del settore agricolo, le donne mediamente guadagnano 0,82 centesimi per ogni dollaro corrisposto a un uomo.
Le donne, inoltre, hanno meno sicurezza sulla proprietà e sul controllo della terra, godono di un accesso al credito e alla formazione più limitato e devono lavorare con tecnologie progettate massimamente per gli uomini. Al di là degli aspetti discriminatori, tali disuguaglianze creano un divario di genere del 24% a livello di produttività tra uomini e donne impiegati in aziende agricole di pari dimensioni.
Lo studio FAO evidenzia, in particolare, che in molti Paesi i sistemi agroalimentari rappresentano una fonte di sussistenza più importante per le donne che per gli uomini. Per esempio, nell’Africa subsahariana, il
66% delle donne è occupato in questo settore rispetto al 60% degli uomini, mentre nell’Asia meridionale la stragrande maggioranza delle donne che lavora è impiegata nei sistemi agroalimentari (il 71% delle donne, rispetto al 47% degli uomini). Un dato che però è diretta conseguenza del basso livello di sviluppo economico dei Paesi, in cui l’istruzione inadeguata, l’accesso limitato alle infrastrutture e ai mercati di base, l’elevato carico di lavoro non retribuito e le scarse opportunità di impiego al di fuori dell’agricoltura, limitano di fatto costitutivamente la condizione di un empowerment femminile. Anche l’emigrazione maschile contribuisce a elevare i numeri dell’occupazione femminile in agricoltura, ma anche in questo caso il dato non può essere associato a un miglioramento della condizione femminile. Tutt’altro: il fenomeno emigratorio può spesso innescare profondi squilibri nella divisione del lavoro e nelle relazioni all’interno della famiglia, perché in un contesto comunque regolato da norme e dinamiche di potere discrimi-

Il settore agroalimentare rappresenta a livello
natorie, la disuguaglianza di genere tocca i mezzi di sussistenza, l’accesso alle risorse e al credito, l’opportunità di istruzione e formazione, la possibilità di inserimento in una rete sociale, nonché la partecipazione nel processo decisionale all’interno del nucleo familiare sull’uso della terra e del reddito. E a questi ostacoli, aggiunge la FAO, devono sommarsi le ulteriori sfide poste dagli “shock climatici, economici […], dai conflitti e dai crescenti rischi di violenza”. Anche se la partecipazione femminile ai sistemi agroalimentari cambia nel tempo con lo sviluppo economico e sociale di ogni Paese, la condizione di lavoro delle donne continua a essere direttamente in-
fluenzata dagli squilibri di genere nel potere contrattuale all’interno della comunità, della società e dell’umanità.
UN CAMBIAMENTO POSSIBILE
Alla luce di questi scenari, è ancora più necessario dare spazio a quei numeri, quelle informazioni, quelle iniziative che ci parlano di un cambiamento. Un cambiamento possibile e attuabile, come dimostra ciò che è avvenuto in Mozambico: in seguito all’emigrazione maschile si sono registrati un maggiore benessere e una più ampia realizzazione economica delle donne, a dimostrazione che carichi di lavoro più elevati possono condurre a una più grande
autonomia e responsabilità, se regolati da giuste dinamiche.
Considerando l’Italia, i dati del 7° Censimento generale dell’Agricoltura pubblicato dall’ISTAT riportano un calo, rispetto agli anni precedenti, della presenza femminile occupata in agricoltura, il 30% del totale. Si è però rafforzata la partecipazione delle donne nel ruolo manageriale: il 31,5% dei capi di aziende agricole è femminile; e la percentuale più alta si registra nel Mezzogiorno, con una notevole presenza di donne imprenditrici agricole in Molise (40%). Si tratta di un dato positivo, se si considera un ruolo – quello imprenditoriale – storicamente associato alla popolazione maschile.
“Le donne sono da sempre al servizio dei sistemi agroalimentari. che i sistemi agroalimentari siano al servizio delle donne”
Ora è giunto il momento di garantire
FAO, 2023mondiale una tra le principali fonti di impiego femminile (36%), con una percentuale molto ravvicinata a quella degli uomini (38%)

Anche se la partecipazione femminile ai sistemi agroalimentari cambia nel tempo con lo sviluppo economico e sociale di ogni Paese, la condizione di lavoro delle donne continua a essere direttamente influenzata dagli squilibri di genere nel potere contrattuale all’interno della comunità, della società e dell’umanità
I VANTAGGI SOCIO-ECONOMICI DELL’EMANCIPAZIONE E DELLA PARITÀ DI GENERE
“L’efficienza, l’inclusività, la resilienza e la sostenibilità dei sistemi agroalimentari non possono prescindere dall’emancipazione di tutte le donne e dalla parità di genere. Le donne sono da sempre al servizio dei sistemi agroalimentari. Ora è giunto il momento di garantire che i sistemi agroalimentari siano al servizio delle donne”, afferma il Direttore generale della FAO, QU Dongyu, guardando agli effetti positivi che potrebbe avere un’uguaglianza di genere. “Se riusciremo a rimuovere il divario di genere nei sistemi agroalimentari e a favorire l’emancipazione femminile”, sottolinea nella Prefazione al Rapporto FAO 2023 -
QU Dongyu, “il mondo farà passi da gigante verso il conseguimento degli obiettivi della lotta alla povertà e della creazione di un mondo libero dalla fame”.
Secondo lo studio, infatti, se si riuscisse a colmare il divario di genere nella produttività agricola e il divario retributivo tra uomini e donne nel settore agricolo, il prodotto interno lordo, a livello mondiale, aumenterebbe di quasi 1.000 miliardi di dollari, riducendo di 45 milioni il numero di persone afflitte dall’insicurezza alimentare.
Anche i vantaggi scaturiti dai progetti che promuovono l’emancipazione femminile sono maggiori rispetto ai benefici ottenuti da iniziative che si limitano a integrare la dimensione di genere. Gli autori del Rapporto spiegano che, se la metà dei piccoli produttori potesse beneficiare di interventi di sviluppo volti a fornire alle donne strumenti di emancipazione, si osserverebbe un importante miglioramento del reddito di altri 58 milioni di persone, con un conseguente rafforzamento della resilienza per altri 235 milioni di individui.
Nonostante alcuni successi ottenuti nel ridurre i divari di genere nell’accesso alle tecnologie digitali e ai finanziamenti, a distanza di 10 anni dal precedente Rapporto dedicato della FAO, si osserva oggi una stagnazione, se non un’inversione di tendenza rispetto ai progressi compiuti, con conseguenti criticità emergenti a ogni livello, dalla malnutrizione dei bambini nella prima infanzia, alla povertà dovuta a redditi insufficienti, alla difficoltà ad accedere a posti di lavoro di qualità.
Anche se è aumentato lo spazio dedicato alle questioni di genere nei quadri politici nazionali, la disuguaglianza di genere, nei
sistemi agroalimentari, continua a rappresentare un freno per le donne a tutti i livelli e in qualsiasi ruolo.
Il rapporto FAO giunge alla conclusione che un percorso efficace volto alla parità di genere, all’emancipazione delle donne e alla garanzia di sistemi agroalimentari più giusti e sostenibili debba prevedere alcuni step imprescindibili: Colmare i divari in termini di accesso a beni, tecnologie e risorse: gli interventi per migliorare la produttività delle donne hanno successo quando tengono conto del lavoro domestico non retribuito, compresa l’assistenza familiare, quando offrono opportunità di istruzione e formazione e quando rafforzano la sicurezza sulla proprietà e il controllo della terra.
Garantire l’accesso ai servizi di cura dell’infanzia: è fondamentale per le lavoratrici madri. I programmi di sostegno e protezione sociale hanno dimostrato di migliorare l’occupazione e la resilienza della componente femminile della società. Colmare la mancanza di dati di alta qualità disaggregati per sesso, età e altre forme di differenziazione sociale ed economica, in modo da poter monitorare e accelerare i progressi compiuti verso l’uguaglianza di genere nei sistemi agroalimentari. Concludiamo con una perla di saggezza di Qu Dongyu: “Ogni giorno ha un significato particolare, ma tutti i giorni hanno un tema che li accomuna, l’uguaglianza”.
https://unric.org/it/nuovo-rapportofao-la-parita-di-genere-nei-sistemiagroalimentari-vale-1-000-miliardi-di-dollari-per-leconomia-globale-e-puo-salvare-45-milioni-di-persone-dallinsicurezza-alimentare/ https://it.wfp.org/uguaglianza-digenere


Stefania Milanello Esperta in impianti alimentari e divulgatrice scientifica
PERFETTI VAN MELLE È IL SECONDO PLAYER AL MONDO NEL MERCATO CONFECTIONERY (CHEWING GUM E CARAMELLE). L’ANALISI DELLE NECESSITÀ DEI CONSUMATORI, IDEE, NUOVI INGREDIENTI, INNOVAZIONI
SCIENTIFICHE E TECNOLOGICHE RENDONO POSSIBILE LA NASCITA DI PRODOTTI INNOVATIVI E ICONICI. ATTENZIONE ANCHE ALLA RIDUZIONE DELL’IMPATTO AMBIENTALE DELLE PROPRIE ATTIVITÀ
Perfetti Van Melle è uno dei maggiori produttori e distributori al mondo di caramelle e gomme da masticare, con marchi presenti in oltre 150 paesi. È stata fondata nel marzo 2001 quando Perfetti Spa ha acquisito Van Melle, creando la seconda più grande azienda dolciaria mondiale. Nel 2006 Perfetti Van Melle ha acquisito l’azienda spagnola Chupa Chups e, nel 2023, 11 iconici marchi di gomme da masticare e caramelle da Mondelēz in Europa e Nord America.
Se la storia del Gruppo inizia nel 2001, quella di Van Melle e Perfetti ha origini ben più lontane. Siamo nel 1900 quando Izaak Van Melle avvia una piccola attività dolciaria a Breskens riconvertendo la panetteria fondata 60 anni prima da suo nonno. Nel 1932, i fratelli Michael e Pierre Van Melle partono per la Polonia dove imparano un procedimento per produrre frutti di bosco da masticare. Dal viaggio portano l’originale “Tell Dough” nei Paesi Bassi, quindi la cre-
azione di Fruittella. Basandosi sulla ricetta della Fruittella si ispirano a creare una caramella al gusto di menta piperita che in seguito verrà chiamata Mentos. La seconda guerra mondiale distrugge la fabbrica Van Melle Breskens, costringendo l’azienda a trasferirsi a Rotterdam.
Nel 1946, i fratelli Ambrogio ed Egidio Perfetti fondano il Dolcificio Lombardo, producendo dolci e bonbon a Lainate (Milano). L’azienda cambia nome in Perfetti nel 1970. A metà degli anni Cinquanta viene avviata la produzione di gomme da masticare, lanciando la prima gomma, Brooklyn, interamente prodotta in Italia. Negli anni, Perfetti lancia diversi marchi di caramelle e gomme da masticare che continuano a deliziare i consumatori oggi: Big Babol, Morositas, Vigorsol, Happydent, Vivident e Alpenliebe. Nel 2006, PVM acquisisce il 100% di Chupa Chups, il gruppo spagnolo a conduzione familiare famoso per i marchi Chupa Chups e Smint.
Negli anni 2000, PVM espande le proprie attività in Europa, Asia e Africa costruendo

Gianni Baldi, Process & Technology Director PVM Italia Group
nuove unità produttive in Sri Lanka, Bangladesh, Spagna, India, Vietnam, Cina e Nigeria. Si amplia anche la gamma prodotti, con tanti nuovi prodotti e marchi in tutto il mondo. A Gianni Baldi, Process & Technology Director PVM Italia Group, abbiamo chiesto
di parlarci di come nascono i nuovi prodotti in PVM, delle linee e macchinari innovativi, ma anche di strategie per ridurre l’impatto ambientale delle proprie attività.
PVM produce un’ampia gamma di prodotti dolciari. Qual è l’iter per la loro nascita e creazione?
In Perfetti Van Melle la richiesta di sviluppo di un nuovo prodotto può derivare da diverse fonti. L’analisi delle necessità dei consumatori, effettuata dal reparto Marketing, rappresenta comunemente la principale fonte di ispirazione per l’innovazione. Un esempio recente è la linea di caramelle jelly Fruittella Veggy-Amici, ideata per rispondere alle esigenze dei consumatori orientati verso un’alimentazione vegana o vegetariana. Altre fonti di ispirazione possono essere la disponibilità di nuovi ingredienti, innovazioni scientifiche in settori correlati che trovano applicazione nelle nostre tipologie di prodotti, o richieste specifiche provenienti dai nostri principali retailers. Il nostro processo di progettazione di un nuovo prodotto è gestito tramite il flusso “stage and gate”, che prevede fasi ben definite (stage) e checkpoint (gate) durante il processo di sviluppo, garantendo una gestione efficace di tutto il percorso. Cinque sono le fasi fondamentali: la prima fase è il “Project Brief”, dove vengono definite le caratteristiche sensoriali, fisiche e analitiche del prodotto oggetto di sviluppo e che costituisce una guida chiara per i vari dipartimenti coinvolti nella progettazione. Superata la fase di approvazione del “Project Brief” si procede alla realizzazione di prototipi nei nostri laboratori dove è possibile replicare su scala ridotta tutte le nostre tipologie di prodotto. Qui vengono effettuati tutti i test necessari per individuare potenziali problematiche e prepara-

re i campioni da sottoporre a valutazione. Dopo l’approvazione del prototipo di laboratorio si passa al terzo stage di “industrializzazione” che ci consente di ottenere il prodotto finito su scala industriale. La penultima fase del processo è costituita dalle analisi e dai controlli delle caratteristiche chimico-fisiche e sensoriali del prodotto finito. Completata questa fase di analisi e verifica, si passa alla validazione, un passaggio chiave per confermare che il prodotto sia idoneo per il lancio sul mercato e soddisfi i requisiti iniziali di progetto. La variabilità dei tempi di sviluppo è legata alla complessità dell’innovazione che si sta introducendo. Per innovazioni relativamente semplici, come ad esempio una nuova aromatizzazione, il processo può richiedere circa 8 mesi dalla concezione dell’idea alla produzione per il lancio sul mercato. In situazioni di innovazione più complessa, che richiedono nuovi formati o ingredienti, il periodo di sviluppo può estendersi a oltre un anno. Quando si introducono prodotti contenenti ingredienti funzionali il processo può richiedere anche più di due anni.
Ci può fare qualche esempio?
Circa il 20% del fatturato del Gruppo Perfetti Van Melle è generato da nuovi prodotti, lanciati al massimo negli ultimi 36 mesi. Con questo alto tasso di innovazione abbiamo dunque tante case history. Quella di Fruittella Onde Frizz 8 pezzi è interessante perché l’innovazione riguarda non solo il formato del prodotto ma anche il formato del packaging. Si tratta di una caramella vegana estrusa e confezionata in un pratico flow-pack. L’obiettivo di questa innovazione è quello di declinare uno dei nostri prodotti best sellers, le Onde Frizz Fruittella, in un formato che risponda alle esigenze per un consumo on-the-go mirato alla distribuzione sul canale del mercato tradizionale (bar e tabacchi). A tal proposito è stato riprogettato il processo di estrusione ad alta capacità e attivato un fondo linea con un sistema di allineamento per ottenere la caratteristica sovrapposizione del prodotto. Tramite specifici sistemi di guide, si ottiene il confezionamento in flow-pack e il riempimento del packaging secondario attraverso un sistema robotico di pick & place. Un’in-

novazione che ha coinvolto molte funzioni oltre alla Ricerca e Sviluppo e ha implicato anche cambiamenti di processo e di impianti produttivi.
Prodotti innovativi richiedono tecnologie, modalità produttive e macchinari all’avanguardia. Ce ne può parlare?
Presso la nostra sede di Lainate abbiamo installato recentemente una nuova linea di confezionamento molto innovativa che ci ha consentito di portare sul mercato un nuovo imballaggio realizzato per il 90% in materiale base carta. Il restante 10% è costituito da plastica e alluminio, che contribuiscono a garantire sia la sicurezza che la conservazione del prodotto. Si tratta del primo barattolo per chewing gum e caramelle con tale quota di fibre vergini che ci consentono di garantire l’elevata qualità e sicurezza dei nostri prodotti. Il materiale carta è certificato “FSC misto”, ossia il legno utilizzato nella sua produzione proviene da foreste gestite in modo responsabile e sostenibile. Il barattolo è riciclabile in tutti i Paesi in cui è in vigore
un programma di raccolta/riciclaggio: in Italia può essere conferito nella raccolta carta. Inoltre, soddisfa i requisiti di protocolli di test volontari, come la norma UNI 11743:2019 per la valutazione della riciclabilità dei materiali a base cellulosa simulando le principali fasi dei processi industriali per il riciclo della carta. Ad oggi abbiamo la possibilità di realizzare barattoli in tre dimensioni: da 50, 80 e 100 pezzi. La linea, attiva da settembre 2021, è stata progettata, costruita, installata e avviata nell’arco di 15 mesi. La linea è molto innovativa perché integra alcune nuove tecnologie produttive per migliorare le condizioni di lavoro, aumentare la produttività degli impianti. La nuova linea di confezionamento prevede postazioni degli operatori ottimali per la gestione dei flussi e la raccolta di dati e di parametri di processo è effettuata in tempo reale. La linea è connessa con i sistemi gestionali a monte e i sistemi gestionali di magazzino a valle, prevede anche l’interconnessione per assistenza tecnica in remoto di ciascuna componente dell’impianto.
Quali soluzioni sta adottando l’azienda per ridurre l’impatto ambientale delle proprie attività?
Il nostro Gruppo ha sviluppato una strategia globale per la sostenibilità con obiettivi che riguardano sia l’impatto ambientale delle nostre attività produttive e distributive sia il packaging dei nostri prodotti. In particolare, abbiamo sottoscritto l’impegno con Science Based Target, per garantire che gli obiettivi di riduzione del nostro impatto siano allineati ai criteri scientifici e alle raccomandazioni di Science Based Targets Initiative. In Italia abbiamo già ottenuto risultati positivi su tutti questi fronti. In particolare, grazie all’acquisto e utilizzo di energia proveniente esclusivamente da fonti rinnovabili e a interventi di efficientamento energetico abbiamo ottenuto una riduzione significativa della CO2 di oltre il 35% rispetto al 2016, a fronte di un incremento dei volumi produttivi del 19%. Dal 2024 avremo anche una quota di energia rinnovabile autoprodotta, grazie all’installazione di impianti fotovoltaici in tutte le nostre principali sedi produttive. In termini di consumi di acqua stiamo ottenendo risultati molto positivi grazie all’ottimizzazione dei cicli di lavaggio e a una serie di interventi di miglioramento su tutti gli impianti di trattamento dell’aria che utilizzano la risorsa “acqua”.
Anche sul fronte della riduzione degli scarti produttivi abbiamo attivato vari progetti riducendo il volume dei rifiuti solidi del 19% dal 2016.
In ambito packaging abbiamo obiettivi di riduzione della plastica del 15% per tonnellata di prodotto entro il 2025. In questo ambito abbiamo portato avanti tanti numerosi progetti a livello globale: eliminazione di packaging superfluo, introduzione di materiali alternativi. Particolarmente significativo, il passaggio da plastica a carta per il bastoncino di Chupa Chups. In Italia utilizziamo principalmente carta come materiale di packaging. Il cartone e la carta del packaging primario di tutti gli astucci, degli stick e delle buste provengono da fonti forestali gestite in modo responsabile e certificate FSC.
La crescente richiesta di alimenti più sani e naturali da parte dei consumatori ha spinto a esplorare soluzioni naturali innovative come alternativa agli ingredienti sintetici. Nel mondo dei prodotti da forno, il problema dell’ossidazione e dell’irrancidimento porta allo sviluppo di odori sgradevoli e di aromi stantii, compromettendo la qualità complessiva dei prodotti da forno secchi come grissini, biscotti, fette biscottate, cracker, etc. Questo deterioramento influisce non solo sugli aspetti sensoriali, ma riduce anche la durata di conservazione, ponendo una sfida ai produttori che cercano di preservare la freschezza e l’attrattiva dei prodotti, cercando contemporaneamente di ridurre al minimo gli sprechi alimentari. In questo contesto, la combinazione di specifici aromi naturali, tra cui l’estratto di oliva, si è rivelata la strategia ideale. Questi ingredienti, che contengono naturalmente composti bioattivi, forniscono un profilo aromatico equilibrato e, come beneficio secondario, possono contribuire a ridurre gli effetti negativi dell’ossidazione, mentre i polifenoli e i flavonoidi agiscono contro i radicali liberi, ritardando efficacemente il processo di ossidazione e l’irrancidimento.
Esalta il sapore dei tuoi prodotti da forno con OLESSENCE B Liquid. Eleva la tua offerta per distinguerti in un mercato sempre più competitivo scegliendo una soluzione naturale, innovativa e label-friendly. Unisciti alla rivoluzione per conservare il gusto e la qualità grazie alla forza della natura: ordina oggi stesso OLESSENCE B Liquid e scopri la differenza con i tuoi occhi!


a cura della Redazione
L’innovazione tecnologica è ciò che connette tutte le soluzioni Antares Vision Group, in evidenza le innovazioni per il controllo qualità attraverso le tecnologie di ispezione per il settore food.
§ Ispezione a microonde. La tecnologia a microonde permette di individuare corpi estranei a oggi non rilevabili con le attuali tecnologie come raggi X e metal detector. Attraverso la differenza delle caratteristiche dielettriche (proprietà di conduttività elettrica) fra prodotto e contaminante diventa possibile rilevare vetro, insetti, legno, sassi, ossa e plastiche a bassa densità, oltre che al metallo.
§ ALL-IN-ONE: un’unica macchina che integra più tecnologie in grado di sod-

disfare molteplici esigenze di qualità e sicurezza del prodotto e del packaging, partendo dall’analisi dei possibili difetti (ad esempio, l’area di saldatura, la corretta applicazione dell’etichetta o controllo del peso).
§ Controllo tappo-livello: un’unica macchina che integra il controllo di livello e la presenza e difettosità dell’applicazione del tappo all’interno di un prodotto


imbottigliato o di una lattina, scartando i prodotti non conformi. Il sistema di ispezione è in grado di eseguire il controllo del livello su ogni tipo di bevanda e tipologia di tappo attraverso le sue molteplici configurazioni: visione, alta frequenza e raggi X.
Antares Vision Group
www.antaresvisiongroup.com
Nella grande distribuzione, i pallet sono utilizzati per lo stoccaggio e la movimentazione dei beni di consumo. Questi imballaggi, a fine utilizzo, possono essere considerati rifiuti ingombranti e difficili da trattare, con conseguenze negative per l’ambiente e per l’economia. Per questo Relicyc, attraverso il ritorno di pallet da riciclare, offre alle grandi catene una soluzione innovativa e sostenibile, generando un circolo virtuoso che fa bene all’ambiente e riduce i costi, perché il sistema di recupero dei pallet in legno di Relicyc limita gli sprechi di materiale postconsumo.
Al contempo, il cliente può partecipare attivamente al processo di riciclo e diventare un vero e proprio partner, fornendo lui stesso la materia prima con la quale poi verranno realizzati i suoi prodotti. In questo modo viene incentivata la circolarità dei materiali, creando una relazione win-win tra azienda e clienti, che potranno così ottimizzare i co-


sti di smaltimento degli imballaggi plastici a fine utilizzo e ottenere un guadagno aggiuntivo proporzionale al quantitativo di plastica conferito.
Relicyc, infatti, preleva i materiali presso le sedi delle aziende partner – ottimizzando in modo significativo il dispendio energetico, con una notevole riduzione delle emissioni di anidride carbonica – li trasporta presso le proprie sedi per le operazioni di riciclo e trasformazione in pallet o in cestini o carrelli per la spesa, nuovamente riciclabili al 100%.
Snodo centrale in questo processo anche la collaborazione con Certified Recycled Plastic®, il programma tecnologico che traccia in maniera immutabile e verificabile le risorse plastiche lungo l’intera filiera del riciclo. Punto di forza è infatti la tecnologia Blockchain, che permette di raccogliere le informazioni relative ai materiali lotto per lotto attraverso QR code univoci assegnati a ciascuno lotto di pallet.
Relicyc
www.relicyc.com
L’ERP CSB-System è un software completo, integrato e multilingue, specifico per il settore dei prodotti dolciari e da forno. La struttura modulare del software consente di introdurre nuove funzionalità in modo flessibile, nel momento in cui lo si desidera. Statistiche e report liberamente definibili sono disponibili in qualsiasi area aziendale.
Acquisizione flessibile e integrata dei dati
Grazie alla raccolta dei dati lungo la filiera là dove questi sono generati, l’ERP CSBSystem aiuta a strutturare e ottimizzare i processi, così da massimizzare l’efficienza della produzione, del magazzino e della logistica. L’acquisizione dei dati operativi può avvenire tramite PC industriali (ad es. il CSB Rack) solitamente posizionati nelle aree di ricevimento merci, produzione e confezionamento oppure con dispositivi mobili. La tracciabilità è garantita senza lacune.
Chiara pianificazione
della produzione
Gli ordini di produzione sono visualizzati graficamente su diversi orizzonti temporali; possono essere ottimizzati automaticamente, tenendo conto delle sequenze di produzione impostate, per es. prima i prodotti biologici, poi i convenzionali e alla fine gli allergeni.
Accesso mobile ovunque
CSB-System archivia in cloud in tempo reale i dati, indipendentemente dal luogo in cui questi sono generati, e questi possono essere consultati ovunque e in qualsiasi momento, se in possesso dei permessi necessari. Negli ultimi anni diverse CSB web solutions sono state consolidate nell’ERP.
Collegamento alle macchine tramite sistemi MES e manutenzione predittiva Con l’avvento dell’Industria 4.0, la quantità di dati provenienti dagli impianti di produzione



e confezionamento è diventata enorme. Il MES, sistema di esecuzione e controllo della produzione, è parte integrante dell’ERP CSB-System; visualizza i dati delle macchine, i dati di produzione e le risorse e, sulla base

di queste informazioni, monitora il processo produttivo in tempo reale.
Con l’attivazione dell’impianto fotovoltaico presso il Caseificio di proprietà Colline di Selvapiana e Canossa sull’Appenino Reggiano, DalterFood Group compie un ulteriore passo concreto nell’essere sempre più sostenibile. L’impianto, dalla potenza nominale da 100KW/ora, consente la produzione autonoma del 30% del fabbisogno di energia elettrica.
Oltre a questi investimenti, altri importanti progressi sono stati fatti da DalterFood Group, sempre in ottica di sostenibilità, sul fronte della gestione dei rifiuti, come ad esempio, quelli generati da imballaggi in plastica, oggi ridotti del 31% rispetto ai livelli del 2021.
In particolare, ad oggi, sono attivi tre sistemi di raccolta differenziata: due com-


pattatori per plastica e cartone; grandi sacchi per la raccolta del monomateriale PE (polietilene trasparente), cioè una plastica specifica con una apposita procedura di fine vita e indifferenziato generico. Questi sistemi consentono di
separare i rifiuti, sia nelle aree di produzione che negli uffici, con un conseguente aumento della quota da recuperare e riutilizzare.
DalterFood Group www.dalterfood.com
Le soluzioni di automazione integrata che propone ifm per il settore food e agricolture vengono sviluppate allo scopo di tutelare al massimo i consumatori. È un obiettivo che trova piena applicazione nella fornitura di prodotti e servizi capaci di garantire, in termini di igiene alimentare, processi all’insegna dell’assoluta trasparenza per ciò che concerne lavorazione, confezionamento e catena del freddo.
Sono tre i principali rischi da scongiurare in materia di sicurezza alimentare: la presenza di corpi estranei, le contaminazioni microbiologiche e chimiche e una gestione non accurata, e per questo inaffidabile, delle temperature.
Un processo CIP, da intendersi come i procedimenti di pulizia interna di un’apparecchiatura senza la rimozione o lo smontaggio di parti della stessa, può essere condotto in maniera inadeguata e tale da generare residui chimici i quali, oltre a elevare sensibilmente il pericolo di cui sopra, possono


pregiudicare la sicurezza della produzione a valle. Grazie ai sensori di conducibilità LDL di ifm è invece possibile conoscere lo stato del processo CIP in modo da poterlo eseguire efficacemente.
Per quanto concerne il controllo costante e puntuale della temperatura durante la lavorazione e lo stoccaggio in processi sensibili come la sterilizzazione UHT e la lavorazione
del latte (pena il rischio tangibile di una proliferazione batterica), ifm risolve il problema alla radice. Lo fa grazie al proprio sensore di temperatura TCC che ne controlla efficacemente la precisione segnalando una deriva oltre l’intervallo di tolleranza nel caso essa si manifesti.
IFM ELECTRONIC www.ifm.com

SAVE THE DATE
Dal 24 al 26 settembre 2024 i protagonisti del settore si incontrano per discutere dei temi cruciali e delle principali sfide che attendono il mondo della produzione alimentare III edizione



Stefania Milanello
Esperta in impianti alimentari e divulgatrice scientifica
NEL 2022 I PRODOTTI DOP E IGP SONO CRESCIUTI NONOSTANTE LE DIFFICOLTÀ RELATIVE ALLE EMERGENZE
Il comparto agroalimentare DOP IGP raggiunge 8,85 miliardi di euro (+8,8%), mentre il settore vitivinicolo 11,3 miliardi di euro (+4,6%). Il Rapporto, giunto alla XXI edizione, fotografa i numeri del comparto del cibo e vino italiano e dei prodotti di qualità certificata DOP IGP STG nel 2022. Nasce dalla sinergia fra l’Osservatorio Qualivita e l’Osservatorio Ismea, con la collaborazione di Origin Italia, dei Consorzi di tutela, degli Organismi di Controllo e delle autorità pubbliche di vigilanza (ICQRF, DIQPAI). Dal Rapporto Ismea-Qualivita emerge che la DOP economy nel 2022 è riuscita a crescere nonostante le difficoltà relative alle emergenze climatiche, alle problematiche fitosanitarie e alla fluttuazione dei mercati. I risultati sono stati ottenuti sottoponendo un questionario ai Consorzi di Tutela e alle Associazioni dei produttori. I dati raccolti sono analizzati con la col-
laborazione di Ismea e raffrontati con le informazioni fornite dagli Organismi di controllo. I dati del Rapporto IsmeaQualivita 2023 riguardano lo scenario europeo e italiano prodotti DOP IGP STG, i dati produttivi ed economici settore italiano cibo e vino IG, i dati economici territoriali e l’impatto regionale DOP IGP, i dati relativi alla GDO e infine le emergenze, lo sviluppo e la sostenibilità del sistema delle IG.
Il Rapporto fa notare che “pur tenendo presente che la crescita dei dati economici è in buona parte determinata dalla spinta inflattiva, la DOP economy italiana evidenzia risultati di grande solidità”. Il sistema delle IG coinvolge oltre 195.000 imprese delle filiere cibo e vino, con un numero di rapporti di lavoro stimati per la prima volta a 580 mila unità nella fase agricola e a 310 mila nella fase di trasformazione e 296 Consorzi di tutela.
Secondo quanto riportato dal Rapporto, il valore complessivo della produzione certificata DOP IGP agroalimentare e vinicola nel 2022 supera per la prima volta la soglia dei 20 miliardi di euro (20,2 miliardi €) per un +6,4% su base annua e assicura un contributo del 20% al fatturato complessivo del settore agroalimentare nazionale. Risulta che quattro regioni del Nord-Est rappresentano il 55% del valore nazionale delle DOP IGP con 11,1 miliardi di euro (+5,7%), con Veneto e Emilia-Romagna che si confermano le prime regioni per valore economico, mostrando una crescita di quasi il +6% sul 2021.
In termini relativi è però il Nord-Ovest a presentare l’incremento maggiore (+12%), trainato da Piemonte e Lombardia, la regione con la crescita più alta nel 2022 (+318 mln €). Il Centro Italia, guidato dalla Toscana, segna un +4%, mentre l’area Sud e Isole, dopo gli importanti incrementi registrati nel 2020 e nel 2021, avanza di un ulteriore +3%, con un contributo soprat-

Il valore complessivo della produzione certificata DOP IGP agroalimentare e vinicola nel 2022 supera per la prima volta la soglia dei 20 miliardi di euro per un +6,4% su base annua e assicura un contributo del 20% al fatturato complessivo del settore agroalimentare nazionale
tutto da parte di Campania (+9%), Sardegna (+19%) e Abruzzo (+9%).
Nella maggioranza delle province italiane si è registrato un valore della DOP economy più alto rispetto al 2021 e per 40 di queste si registra una crescita a doppia cifra.
Le produzioni DOP IGP continuano ad avere un peso rilevante anche sul fronte dell’export agroalimentare italiano (19%), con 11,6 miliardi di euro, grazie alla cre-
scita sia del comparto cibo (4,65 miliardi di euro e +5,8% su base annua e un +66% nel decennio, per effetto soprattutto del recupero dei mercati Extra UE +10%) che del vino (6,97 miliardi di euro e +10,0%). Le DOP e IGP vinicole rappresentano a valore quasi il 90% delle esportazioni delle cantine italiane.
Nel mercato interno, le vendite nella Grande Distribuzione Organizzata di
prodotti IG nel 2022 hanno registrato un +2,7% su base annua e un +8,2% nei primi nove mesi del 2023. I prodotti DOP IGP trovano ampio spazio anche nel canale dei discount, soprattutto vino, olio e altri prodotti non freschi. Inoltre, nonostante il prezzo medio sia sempre a un livello nettamente più basso rispetto agli altri canali, il discount mostra nel 2022 i rincari più marcati (+11,6% per i formaggi, +8,9% per il vino). Inoltre, fa notare il Rapporto, il ricorso alle vendite in promozione da parte della GDO, pur mostrando una flessione negli ultimi anni, risulta più elevato per le DOP IGP, a eccezione degli oli di oliva, rispetto ai prodotti generici.
Maria Chiara Zaganelli, Direttore Generale Ismea ha precisato che: “In questi anni il sistema delle IG ha dimostrato una grande capacità di adattamento agli shock e ai nuovi condizionamenti ambientali, leggendo per tempo i segnali dei
Non poteva mancare una citazione alla nuova riforma europea delle Indicazioni Geografiche, che entrerà in vigore nei primi mesi del 2024, e che prevede: procedure abbreviate e semplificate anche per le modifiche dei disciplinari; una più efficace protezione delle IG vendute online o utilizzate come ingredienti in prodotti trasformati e l’estensione dell’ex-officio anche al sistema dei domini Internet, con un sistema di geoblocking immediato di tutti i contenuti illeciti; la tracciabilità del produttore in etichetta e il potenziamento del ruolo istituzionale dei Consorzi di tutela nella gestione delle proprie IG, tra
possibili impatti di fenomeni in atto e la necessità di reagire con nuove strategie. In particolare, il settore ha iniziato a misurarsi con una trasformazione culturale notevole, aprendosi all’innovazione per difendere la propria capacità competitiva: pur preservando i fattori costitutivi della distintività legati a disciplinari produttivi rigorosi e al loro radicamento territoriale, molti marchi DOP e IGP hanno utilizzato la tecnologia per rendere i processi produttivi o distributivi più flessibili e meglio capaci di rispondere a mutamenti di mercato e a vincoli ambientali. Sul fronte della sostenibilità, la sfida della transizione ecologica, fortemente stimolata dalla UE con la strategia Farm to Fork e con la nuova programmazione della Pac, è stata raccolta dalle produzioni di qualità. Nel comparto vinicolo, ad esempio, ha trovato grande diffusione la conversione all’agricoltura biologica; più in generale, molte produzioni DOP e IGP hanno accelerato l’adozione di innovazioni digitali, favorito l’interlocuzione tra Consorzi di tutela per lo scambio di buone pratiche e accolto la revisione dei disciplinari nell’ottica di affrontare criticità esogene al processo produttivo, come quelle climatiche”.
Rosati ha posto l’accento sulla necessità di “una razionalizzazione che permetta ai territori un governo meno conflittuale”. Nel DDL “Made in Italy” viene introdotto, tra le altre cose, il cosiddetto “Distretto del prodotto tipico”, che, secondo Rosati “andrebbe a incrementare le tipologie di soggetti delegati dal legislatore alla governance territoriale nel settore agroalimentare. Dal 1991 ai giorni nostri, con la formula sintetica “Distretti e sviluppo rurale” sono state definite attraverso le normative europee, nazionali e regionali una pluralità di figure dedicate allo sviluppo locale, prive ad oggi di un quadro di regolazione unitario. Questa situazione evidenzia sui territori una competizione fra i diversi soggetti aggregativi riconosciuti. Una sovrapposizione di ruoli che crea confusione e disorientamento soprattutto alle imprese delle filiere DOP IGP, che da sempre hanno avuto nei Consorzi di tutela un valido riferimento per la loro crescita. Attualmente in Italia oltre ai 296 Consorzi di tutela riconosciuti, si contano circa 220 GAL, 76 Distretti agricoli e rurali, 43 Distretti del cibo, 31
cui l’estensione della programmazione produttiva, la possibilità di istituire un elenco di pratiche sostenibili.
Per Mauro Rosati, Direttore Generale Fondazione Qualivita: “Se da un lato la recente approvazione della Riforma europea sul sistema IG prevista nella strategia Farm to Fork rappresenta un elemento di grande opportunità, dall’altro fattori come le emergenze climatiche, le problematiche fitosanitarie, la fluttuazione dei mercati internazionali, la crescente inflazione degli ultimi mesi e l’attuazione di alcune norme controverse contribuiscono a creare una condizione
di incertezza per il settore. Per affrontare queste criticità serve un vero e proprio cambio di paradigma, uno sforzo condiviso fra filiere, consumatori, istituzioni e ricerca. La strategia perseguita in questi anni, incentrata solo sulla crescita quantitativa del settore – da 5 miliardi del 2003 ai 20 miliardi del 2023, un valore quadruplicato in 20 anni – non è più sufficiente a garantire il futuro del Made in Italy agroalimentare e in particolare quello delle filiere DOP IGP. Occorre imboccare il più velocemente possibile una nuova strada, quella della coesione e della sostenibilità”.
Biodistretti, senza considerare le numerose reti di imprese e le 315 OP e AOP di settore. Tutto ciò allontana l’agricoltura dalla semplificazione e da una efficace gestione dei distretti, aumentando nel contempo la parcellizzazione delle risorse”.
Altre problematiche che il sistema delle DOP IGP dovrà affrontare riguardano i sistemi di etichettatura, quali Nutri-Score, QR-code per indicare gli ingredienti sulle bottiglie di vino, Health Warning irlandesi, il rallentamento dei processi di apertura dei mercati, soprattutto in materia di accordi multilaterali e protezione delle IG, le nuove tendenze di consumo, come quella che vede protagonista negli Stati Uniti, dei vini a bassa gradazione alcolica o privi di alcol, i cosiddetti vini “NoLo”.
Il Rapporto ha messo in luce anche i problemi dovuti ai cambiamenti climatici, a partire dalla siccità e dall’innalzamento delle temperature, passando per l’alterazione del microclima negli areali di produzione e l’impatto di eventi come grandine e alluvioni. Questi incidono anche sulla diffusione di patologie e contribuiscono a una maggiore vulnerabilità delle produzioni agroalimentari: la peronospora, la flavescenza dorata, l’oidio, il mal dell’esca per il vino; la mosca, la lebbra e la rogna dell’olivo per l’olio; la peste suina per i prodotti a base di carne; la lingua blu e la brucellosi per i formaggi; la cimice asiatica e le malattie fungine per gli ortofrutticoli. Infine, tra le emergenze di grande impatto, il Rapporto rileva anche quelle legate ai predatori e in particolare la diffusione del granchio blu. Dal Rapporto emergono anche i problema dovuti all’incremento dei costi delle materie prime e dei mangimi, segnalato dalla quasi totalità dei consorzi, ma anche alla mancanza di manodopera specializzata, all’urgenza legata alla necessità di efficientamento energetico, ai fenomeni di concorrenza sleale.
 Avv. Chiara Marinuzzi Studio Legale Gaetano Forte
Avv. Chiara Marinuzzi Studio Legale Gaetano Forte
Si aspettava da tempo e il 28 febbraio 2024 è arrivato. Il Parlamento europeo ha approvato il nuovo Regolamento UE sulle indicazioni geografiche (IG). Frutto di una lunga negoziazione tra istituzioni e parti sociali. Il documento rappresenta una novità perché è un testo unico, che riunisce vini, bevande spiritose e prodotti agroalimentari a indicazione geografica, prima articolati in diversi provvedimenti.
L’OGGETTO E LO SCOPO
Il regolamento riguarda le denominazioni di origine protette e le indicazioni geografiche protette dei vini, le denominazioni di origine protette e le indicazioni geografiche protette dei prodotti Agricoli e le indicazioni geografiche delle bevande spiritose. Sono, inoltre, disciplinate le specialità tradizionali garantite e le indicazioni facoltative di qualità. L’obiettivo è la competitività dei produttori, l’equa concorrenza, la buona fede del consumatore nonché la strutturazio-
ne di procedure di registrazione efficienti e agevoli, che tengano conto dell’adeguata tutela dei diritti di proprietà intellettuale. A ciò si aggiunga l’efficacia dei controlli in tutta l’UE e una maggior tutela nei mercati dei paesi terzi.
Tra le principali novità si annoverano
Sostenibilità
Nel disciplinare potranno entrare i temi della sostenibilità attraverso l’eventuale obbligo di pratiche sostenibili (sotto il profilo ambientale, sociale ed economico) da rispettare nella produzione.
Legittimazione e procedura di opposizione
Le domande di registrazione delle IG possono essere presentate solo da un gruppo di produttori richiedente, ossia un gruppo, a prescindere dalla sua forma giuridica, costituito da produttori del medesimo prodotto il cui nome è proposto per la registrazione. Gli enti pubblici
e altre parti interessate possono svolgere un ruolo di assistenza.
Ogni Stato membro dovrà regolare la propria procedura nazionale di opposizione (situazione in cui spesso si arenano le domande di registrazione), garantendo la pubblicazione della domanda di registrazione e prevedendo un periodo di almeno un mese per l’opposizione.
Tempi
Accelerazione dei tempi per l’esame comunitario e maggiore trasparenza. L’esame è effettuato entro sei mesi dalla domanda. Se la Commissione dovesse richiedere informazioni supplementari, il periodo di esame delle stesse non supera i cinque mesi a decorrere dal giorno in cui la Commissione riceve la risposta del richiedente.
Se l’esame non si conclude nei tempi suddetti la Commissione informa il richiedente dei motivi del ritardo, indicando il tempo stimato necessario per concludere l’esame, che non può superare un mese.

di ulteriori strumenti di tutela e sviluppo proteggeranno Il rafforzamento dei Consorzi di Tutela e la messa a disposizione un settore sempre più importante nello scenario nazionale
La procedura può subire sospensioni connesse alla pendenza di controversie giudiziarie nello stato membro richiedente.
L’opposizione a livello comunitario va fatta entro 3 mesi dalla pubblicazione sulla GUCE con altri 3 mesi per le consultazioni.
Notifiche di osservazioni È uno strumento nuovo consistente nella possibilità, per le autorità di uno Stato membro o di un paese terzo o una persona fisica o giuridica di un paese terzo, di evidenziare eventuali errori o informazioni supplementari, compresa la possibile violazione di norme dell’Unione, entro tre mesi dalla data di pubblicazione della domanda.
Non è un’opposizione, ma può portare la Commissione a effettuare una nuova pubblicazione.
Nei considerando viene identificata l’“evocazione” come il collegamento con
il prodotto designato dall’IG, anche con riferimento a un termine, segno o altro aspetto dell’etichettatura o dell’imballaggio, presente nella mente del consumatore europeo medio ragionevolmente informato, attento e avveduto. Estesa la protezione delle IG anche ai servizi e ai prodotti usati come ingredienti. Ravvisata usurpazione, imitazione o evocazione, anche al caso di una trascrizione o una traslitterazione e perseguibile l’attività illecita anche nelle informazioni fornite su interfacce online.
Ingredienti DOP/IGP
Per la prima volta viene disciplinato l’uso di ingredienti DOP e IGP nei prodotti trasformati. I limiti sono:
a) il prodotto trasformato non contiene alcun altro prodotto comparabile all’ingrediente designato dall’indicazione geografica;
b) l’ingrediente designato dall’indicazione geografica è utilizzato in quantità sufficienti a conferire una caratteri -
stica essenziale al prodotto trasformato in questione;
c) la percentuale dell’ingrediente designato dall’indicazione geografica nel prodotto trasformato è indicata in etichetta.
Chi intende usare ingredienti DOP/IGP nel nome dell’alimento preimballato, compreso nel materiale pubblicitario, fornisce una notifica preventiva scritta al gruppo di produttori riconosciuto, se esiste, per l’IG in questione.
Entro quattro mesi o viene dato riscontro o viceversa sussiste un silenzio assenso che consente l’uso in capo all’operatore.
È possibile stipulare, con il gruppo di produttori, accordi contrattuali sugli aspetti tecnici e visivi specifici del modo in cui l’indicazione geografica dell’ingrediente è presentata nel nome dell’alimento preimballato nell’etichettatura al di fuori dell’elenco degli ingredienti o nel materiale pubblicitario.

nio identico all’indicazione geografica in questione. L’obiettivo è garantire una più ampia efficacia alla tutela delle IG.
Nome del produttore
Introdotto, nell’etichettatura, l’obbligo di indicare il nome del produttore o dell’operatore nello stesso campo visivo della IG. Il nome dell’operatore è inteso come il nome dell’operatore responsabile della fase di produzione in cui è ottenuto il prodotto che deve essere oggetto dell’indicazione geografica o responsabile della trasformazione sostanziale di tale prodotto.
Tutela online
Rafforzata la tutela online. Tutte le informazioni collegate alla pubblicità, alla promozione e alla vendita di prodotti e che violano la protezione delle IG sono considerate contenuti illegali in base al Regolamento (UE) 2022/206 sui servizi digitali.
Relazione tra indicazioni geografiche e marchi commerciali
L’annosa questione del rapporto tra marchi e IG viene definita, prevedendo il rigetto della domanda di registrazione di un marchio commerciale, in violazione delle norme di protezione, se successiva alla data di presentazione della domanda di registrazione della IG.
I marchi UE registrati in violazione di tale disposizione sono dichiarati nulli dall’EUIPO mentre quelli nazionali sono dichiarati nulli dalle autorità nazionali competenti. Ammessa la coesistenza IG e marchio anteriore, ossia depositato, registrato o acquisito in buona fede prima della data di presentazione alla Commissione della domanda di registrazione della IG, anche se viola le norme di protezione.
Gruppi di produttori (Consorzi di Tutela) Ampio spazio viene dato (artt. 32 ss) ai Gruppi di produttori di cui vengono indi-
cate le caratteristiche, i requisiti di composizione, le facoltà e i poteri. In sostanza si tratta dei Consorzi di Tutela a cui vengono riconosciuti maggiori poteri di intervento, potere di rilasciare le autorizzazioni all’uso degli ingredienti IG, ulteriore possibilità di definire la regolamentazione dell’offerta, diritto di concordare pratiche sostenibili, chiedere modifiche e cancellazione delle IG.
Nomi a dominio
Il regolamento tiene in considerazione il possibile conflitto tra le IG e i nomi a dominio.
La Commissione potrà affidare all’EUIPO il compito di istituire e gestire un sistema di condivisione delle informazioni e di allarme per i nomi di dominio che fornisca al richiedente informazioni sulla disponibilità dell’indicazione geografica come nome di dominio e, facoltativamente, sulla registrazione di un nome di domi-
I prestatori di tali servizi si attivano a seguito della ricezione, dalle autorità competenti dell’ordine di contrasto ai contenuti illegali (es. oscuramenti siti, etc).
Attestazioni di conformità
Nuova la possibilità dell’operatore che ha superato il controllo delle autorità preposte, di richiedere un’attestazione di conformità al disciplinare, anche digitale, o l’inserimento in un elenco di operatori approvati redatto dall’autorità competente.
CONCLUSIONI
La nuova riforma delle indicazioni geografiche costituisce una novità soprattutto per quanto concerne la creazione di un unico testo per tutte le produzioni del mondo dell’agroalimentare, del vino e delle bevande spiritose. Il rafforzamento dei Consorzi di Tutela e la messa a disposizione di ulteriori strumenti di tutela e sviluppo dovrebbero fornire uno strumento più moderno per proteggere un settore sempre più importante nello scenario nazionale.




Economia, scienza, tecnica, sostenibilità e innovazione

Dal14 al 16 maggio 2024 torna l'appuntamento online di confronto e approfondimento sui trend tecnologici, economici e ambientali della filiera lattiero - casearia
SAVE THE DATE 14, 15 e 16 maggio 2024
www.lat
L’AMBIENTE DI PRODUZIONE DEVE ESSERE PROGETTATO E COSTRUITO IN MODO DA LIMITARE LE CONTAMINAZIONI AMBIENTALI. NORME COGENTI E VOLONTARIE DANNO INDICAZIONI IN TAL SENSO
Nella prevenzione delle contaminazioni anche l’ambiente gioca un ruolo cruciale, dove per ambiente si intendono le infrastrutture installate, gli impianti, i muri, l’aria. Tutti questi elementi rientrano nell’ambito dei prerequisiti, definiti come condizioni ambientali e operative di base di un’azienda alimentare, necessarie per produrre alimenti sicuri. Il programma di prerequisiti, invece, contiene prassi e condizioni di prevenzione che includono tutte le corrette prassi igieniche, oltre che procedure quali la formazione del personale e la rintracciabilità.
“Questi sono i presupposti”, commenta Serena Pironi, Tecnologa Alimentare.
“Un’azienda alimentare lavora bene quando implementa in maniera solida il programma dei prerequisiti. Qui, infatti, tro-


Elena Consonni giornalista esperta in scienze e tecnologie alimentari
viamo le leve giuste per tenere a bada le contaminazioni ambientali”.
I prerequisiti sono disciplinati da diverse norme, cogenti e volontarie, a partire dal Regolamento Igiene, il Reg. CE 852/2004 e s.m.l., che in uno degli allegati riporta alcune indicazioni operative. Infatti precisa che le strutture destinate agli alimenti devono essere tenute pulite, sottoposte a manutenzione e tenute in buone condizioni. Lo schema, la progettazione, la costruzione, l’ubicazione e le dimensioni delle strutture destinate agli alimenti devono essere tali da impedire l’accumulo di sporcizia, il contatto con materiali tossici, la penetrazione di particelle negli alimenti e la formazione di condensa o muffa indesi-
derabile sulle superfici. “In pratica”, precisa Pironi, “introduce il concetto di disegno igienico degli impianti”.
Sempre l’allegato specifica che si deve assicurare una corretta aerazione meccanica o naturale, evitando il flusso meccanico di aria da una zona contaminata verso una zona pulita. I sistemi di aerazione devono essere tali da consentire un accesso agevole ai filtri e alle altre parti che devono essere pulite o sostituite.
“Nella mia attività consulenziale”, spiega, “mi sono resa conto che questo punto talvolta è trascurato. La sovrapressione tra un ambiente e l’altro non viene considerata e non si conoscono i flussi di aria. In un caso mi sono resa conto che un problema di contaminazione da muffe derivava proprio da un flusso di aria che dall’esterno arrivava alla zona di confezionamento”.

EFSA sottolinea come alcuni microrganismi alterativi o patogeni possono provenire dall’ambiente e che le condizioni ambientali igieniche durante la produzione sono una causa o un fattore di rischio per la contaminazione incrociata
Il Reg. 852 parla anche delle caratteristiche che devono avere gli impianti di scarico. “La progettazione di scarichi e drenaggi”, commenta Pironi, “è un altro punto debole. Ho lavorato persino con aziende in cui non erano neppure presenti e abbiamo dovuto impostare le procedure di sanificazione a secco”.
Le infrastrutture non devono favorire l’insorgere di contaminazione. Pavimenti, pareti e soffitti devono essere mantenuti in buone condizioni, essere facili da pulire e sanificare. Devono essere costruiti o rivestiti in materiale resistente, lavabile e non tossico.
Le finestre e le altre aperture devono essere realizzate in modo da impedire l’accumulo di sporcizia e quelle che possono essere aperte verso l’esterno devono essere dotate di barriere anti insetto. Le porte devono avere superfici facili da pulire; le superfici nelle zone di manipolazione degli alimenti devono essere mantenute in buone condizioni ed essere facili da sanificare. Si richiedono materiali lisci, lavabili, resistenti alla corrosione e non tossici.
“Un esempio di programma di prerequisiti”, spiega Serena Pironi, “è contenuto nella Linea Guida UE, che mette in correlazione il Codex Alimentarius con le norme ISO. Uno dei punti a cui fa riferimento è il layout degli edifici. Molte aziende nascono con un layout ben strutturato, ma nel tempo vengono ampliate e lo stravolgono, rendendo più difficile gestire gli incroci dei flussi di produzione. Un altro aspetto interessante sottolineato dalla Linea Guida sono le utilities, per esempio l’acqua, che può diventare ghiaccio o vapore ed entrare nei processi, oppure i gas come quelli per i tunnel di surgelazione o per l’atmosfera modificata”.
La Linea Guida precisa che in sede di valutazione dei rischi connessi all’ubicazione dello stabilimento andrebbe tenuto conto della prossimità di potenziali fonti di contaminazione, dell’approvvigionamento idrico, del trattamento delle acque reflue, della fornitura di elettricità, dell’accesso ai trasporti, del clima, di possibili inondazioni. Inoltre la configurazione degli stabilimenti dovrebbe prevedere una rigorosa separazione tra zone contaminate e zone pulite, tra aree ad alto rischio con prodotto esposto e aree a basso rischio. I locali dovrebbero essere disposti in modo da garantire un flusso di produzione unidirezionale (la cosiddetta “marcia in avanti”) e i locali refrigerati o gli impianti di riscaldamento dovrebbero essere isolati.
Un altro aspetto preso in considerazione sono i magazzini. Dovrebbero essere disponibili locali chiaramente definiti per le materie prime, recipienti per alimenti e i materiali da imballaggio. “Ancora oggi”, racconta Pironi, “trovo magazzini non separati. Se ci sono aree comuni, andrebbero comunque creati degli spazi separati per materie prime, imballaggi, prodotto finito”.
Secondo la Linea Guida andrebbe prestata attenzione alle diverse modalità con cui le attrezzature possono provocare contaminazioni. Bisogna prevenire, per esempio, il gocciolamento della condensa dai soffitti, l’accumulo di residui di alimenti nei di-

Lo schema, la progettazione, la costruzione, l’ubicazione e le dimensioni delle strutture destinate agli alimenti devono essere tali da impedire l’accumulo di sporcizia, il contatto con materiali tossici, la penetrazione di particelle negli alimenti
spositivi per l’affettatura. Devono essere utilizzate attrezzature separate per prodotti crudi e cotti.
Rimanendo in ambito comunitario, anche EFSA - Autorità Europea per la Sicurezza Alimentare si occupa di prerequisiti. “Lo ha fatto”, sottolinea Pironi, “in una linea guida emanata nel 2020 che si occupa di come attribuire la shelf life di un prodotto alimentare. EFSA sottolinea come alcuni microrganismi alterativi o patogeni possono provenire dall’ambiente e che le condizioni ambientali igieniche durante la produzione sono una causa o un fattore di rischio per la contaminazione incrociata”.
EFSA suggerisce di prestare attenzione alla progettazione igienica delle superfici, delle attrezzature e degli utensili a contatto con gli alimenti e alla suddivisione in zone degli impianti di lavorazione. “Anche le saldature devono essere igieniche e quindi devono essere realizzate in modo che non possano scheggiarsi onde evitare di contaminare esse stesse gli alimenti”.
Fin qui siamo in ambito cogente, ma anche gli standard di certificazione volontari GFSI
(IFS e BRCGS) sono oggi molto dettagliati sui prerequisiti. I concetti introdotti sono gli stessi di quelli presi in esame dalle norme comunitarie, ma gli standard puntualizzano alcuni dettagli operativi che è necessario rispettare per ottenere la certificazione. Lo standard IFS, per esempio, richiede che vengano svolte indagini per rilevare in quale misura l’ambiente circostante allo stabilimento possa avere un impatto negativo sulla sicurezza alimentare e sulla qualità del prodotto. Nel caso si stabilisca che la sicurezza o la qualità del prodotto possano essere compromesse, devono essere implementate adeguate misure di controllo, che devono essere periodicamente riesaminate.
Richiede anche che sia disponibile una mappa del sito produttivo che includa tutti gli edifici e descriva chiaramente i flussi del processo “Questa mappa”, afferma Pironi, “è un buon metodo per gestire i flussi correttamente. Riportando tutti i flussi in un unico documento è facile verificare se tutto il processo procede a marcia avanti o se ci sono incroci e in questo caso aiuta a gestirli”.
Secondo lo standard, infatti, il flusso di lavorazione, dal ricevimento delle merci alla
spedizione, deve essere stabilito, riesaminato e, se necessario, modificato al fine di garantire che i rischi di contaminazione microbiologica, chimica e fisica delle materie prime, del materiale di confezionamento, dei prodotti semilavorati e dei prodotti finiti sia evitato. Le aree giudicate sensibili dalla valutazione del rischio progettate e gestite in modo da garantire che la sicurezza del prodotto non sia compromessa.
“Queste indicazioni, che potrebbero sembrare ovvie”, sostiene Pironi, “sono invece tutt’altro che scontate nella pratica, perché spesso si occupano della progettazione dei siti produttivi figure professionali, come gli architetti, che nulla sanno di igiene degli alimenti e che quindi non tengono conto delle necessità specifiche del settore. Secondo la norma IFS i locali in cui vengono preparati, trattati, lavorati e conservati i prodotti alimentari devono essere progettati e costruiti in modo tale da garantire la sicurezza alimentare. In particolare, le pareti devono prevenire l’accumulo di sporco, i pavimenti devono essere in buone condizioni e facili da pulire e deve essere garantito lo smaltimento igienico delle acque reflue. Le installazioni sospese (tubature, canaline elettriche, lampade) devono essere costruiti in modo da ridurre al minimo l’accumulo di sporco e condensa. In caso di controsoffitti, è necessario un accesso all’area vuota sovrastante per facilitare la pulizia, la manutenzione e le ispezioni per il controllo degli infestanti”.
Un altro aspetto preso in esame è la ventilazione: i filtri e gli altri componenti devono essere facilmente accessibili, controllati, puliti o sostituiti se necessario.
“Lo standard IFS”, prosegue Pironi, “prevede anche un piano di monitoraggio periodico di tutte le attività previste dalla certificazione. Anche i parametri di monitoraggio ambientale devono essere periodicamente verificati. È quindi necessario individuare le superfici da mantenere controllate
e i parametri da determinare. La scelta di cosa monitorare è frutto di un’analisi del rischio”.
Anche lo standard BRCGS contempla che vengano rispettati requisiti simili all’IFS, ma è più preciso su alcuni punti. Per esempio, a proposito della planimetria della struttura, precisare che devono essere mappati oltre ai percorsi di materie prime e prodotti finiti, anche i flussi delle persone, degli imballaggi e dei rifiuti.
Introduce, inoltre, un sistema di classificazione del rischio delle aree dello stabilimento. Le aree ad alto rischio sono quelle destinate trattamento dei prodotti esposti particolarmente sensibili, come refrigerati e congelati. Seguono, a livello di rischio decrescente, le aree ad alto controllo per i prodotti a temperatura controllata; le aree ad alto controllo per le referenze a temperatura ambiente e quelle a basso rischio. Ci sono poi le aree più semplici perché destinate a prodotti confezionati, depositi e magazzini e per finire quelle non destinate al trattamento prodotti, come uffici o spogliatoi. “Dove si individua una zona ad alto rischio o ad alto controllo”, precisa Pironi, “ai fini della certificazione deve essere prevista una segregazione fisica e una compartimentazione aree”.
Ci sono altre differenze rispetto allo standard IFS. Per esempio, nei controsoffitti devono essere collocate delle trappole per le infestanti; i camminamenti sopra le linee devono prevenire cross contaminazione, devono essere facili da pulire e manutenere; scale, piani rialzati, gradini devono essere realizzati con disegno igienico e devono essere puliti e monitorati oltre che manutenuti.
BRCGS precisa anche le procedure da seguire per macchine e attrezzature nuove o rimaste non in uso per molto tempo. Si occupa anche dei muletti, che devono subire una procedura di ripristino igienica se transitano da aree a basso rischio verso quelle
a rischio superiore, e persino delle loro batterie, che devono essere chiuse per non provocare contaminazioni.
“Anche BRCGS”, sottolinea Pironi, “prevede un monitoraggio ambientale, basato sulla valutazione dei rischi (piano campionamento, posizione campioni, frequenza, organismi bersaglio, metodo di analisi, valutazione controlli) con limiti adeguati e azioni correttive”.
COME ESEGUIRE LA VALUTAZIONE DEL RISCHIO
Né lo standard BRCGS né IFS, però, danno delle indicazioni precise su come impostare la valutazione del rischio. In questo viene in soccorso alle aziende la certificazione FSSC2200, che nell’ottobre 2022 ha emanato delle linee guida su come deve essere eseguito il monitoraggio ambientale.
Il primo step è definire il team che se ne occupa e chi è il leader. Poi viene l’analisi del rischio, per cui la certificazione suggerisce di tenere in considerazione diversi aspetti:
§ microrganismi, pericoli specifici del prodotto o che potrebbero provenire da materie prime, ambiente;
§ le aree o le zone in funzione dei differenti pericoli;
§ le tecniche di monitoraggio (tamponi, analisi acqua, piastre aria, tamponi ATP);
§ la corretta frequenza di monitoraggio;
§ il metodo di campionamento, il suo stoccaggio e trasporto per analisi;
§ i limiti oltre i quali definire azioni correttive;
§ il trend dei risultati ottenuti.
Deve seguire una verifica e l’aggiornamento, la redazione della relativa documentazione e la formazione del personale.
Queste linee guida forniscono anche un elenco, seppur non esaustivo, dei microrganismi da tenere in considerazione. Tra i patogeni suggerisce salmonella, Listeria in ambienti umidi, Staphylococcus aureus dove c’è manipolazione da parte degli operatori, Bacillus cereus in caso di prodotti secchi e Campylobacter jejuni in caso di pollame. Tra gli alterativi: lieviti e muffe da aria e superfici; tra gli indicatori di igiene: Coliformi, Enterobatteriacee ed Escherichia coli
“Non è obbligatorio monitorare tutti questi parametri”, sottolinea Pironi, “ma bisogna scegliere cosa tenere controllato in funzione dei propri processi, prodotti e condizioni ambientali”.
Anche queste linee guida parlano di quattro zone diverse in funzione del rischio. Nella Zona 1 rientrano le superfici a diretto contatto (parti interne di tubi o tank, utensili, superfici); nella Zona 2 ci sono le superfici non a diretto contatto ma nelle vicinanze, per esempio pavimenti, controsoffitti muri, unità di condensazione delle celle refrigerate; la Zona 3 comprende le aree più remote, in cui è più improbabile una contaminazione, le aree in sovrapressione, i filtri per l’aria, compressori; la Zona 4 comprende le aree esterne alla produzione o i magazzini dove è stoccato il prodotto chiuso.
“Per una corretta analisi rischio”, sottolinea Pironi, “bisogna valutare reparto per reparto le zone 1 e 2, capire le probabilità che si verifichino delle contaminazioni e decidere la frequenza del campionamento”.

Alcuni prodotti ittici pronti per il consumo, principalmente salmone affumicato, sono la probabile fonte di un focolaio epidemico plurinazionale di Listeria monocytogenes in atto, affermano gli esperti dell’EFSA e del Centro europeo per la prevenzione e il controllo delle malattie (ECDC) in una valutazione rapida del focolaio pubblicata il dicembre scorso. Tra il 2022 e il 2023 il focolaio ha interessato Austria, Belgio, Italia, Germania e Paesi Bassi, con segnalazioni di 17 casi e due decessi. Le infezioni hanno interessato principalmente anziani. Lo storico dei casi nell’uomo connessi al focolaio decorre dal 2011.
Le avanzate tecniche di tipizzazione molecolare hanno permesso di individuare una variante di Listeria monocytogenes che è stata rilevata nella maggior parte dei casi del periodo 2022-2023. L’analisi dei dati suggerisce un collegamento con due stabilimenti in Lituania durante il medesimo periodo. È stato riscontrato che questi stabilimenti avevano riversato prodotti ittici contaminati nei mercati al dettaglio di Germania e Italia. La produzione è stata arrestata in un impianto produttivo lituano per tentare di ridurre il rischio di infezioni. I dati relativi alla distribuzione di prodotti contaminati in Austria, Belgio e nei Paesi Bassi non sono per ora disponibili.
Secondo gli esperti dell’EFSA e dell’ECDC, per individuare l’origine della contaminazione sono necessarie ulteriori indagini, che consentiranno alle autorità nazionali di attuare misure di controllo e azioni di mitigazione mirate. Gli esperti raccomandano inoltre di seguire le buone prassi di fabbricazione, le norme igieniche e un controllo efficace della temperatura lungo l’intera catena di produzione, distribuzione e conservazione degli alimenti, anche in ambito domestico. Si consiglia ai consumatori di mantenere le temperature in frigorifero basse per inibire la potenziale proliferazione di batteri come Listeria, che potrebbero essere presenti negli alimenti pronti per il consumo.

In base alle conclusioni dell’ultima valutazione del rischio da arsenico inorganico effettuata dall’EFSA, l’esposizione dei consumatori a questo contaminante tramite i cibi desta preoccupazioni per la salute. I riscontri attuali confermano l’esito della precedente valutazione EFSA, risalente al 2009, circa i rischi connessi alla presenza di arsenico inorganico negli alimenti. La Commissione europea ha chiesto all’EFSA di aggiornare la valutazione dell’arsenico inorganico tenendo conto di nuovi studi sui suoi effetti tossici. L’EFSA ha consultato i portatori di interesse esterni in merito al proprio progetto di parere e nella redazione conclusiva del parere ha tenuto conto delle numerose osservazioni pervenute.
Quali alimenti contengono arsenico inorganico
L’arsenico è un contaminante largamente diffuso, sia in natura che come risultato di
attività dell’uomo. Si presenta in varie forme, a seconda della sua struttura chimica. Il presente parere dell’EFSA verte sull’arsenico inorganico.
Sono i cibi la principale fonte di esposizione per la popolazione europea in genere. I principali alimenti all’origine dell’esposizione sono il riso e i prodotti a base di esso, i cereali e i prodotti a base di essi. Anche l’acqua potabile contribuisce all’esposizione, benché i tenori in arsenico siano generalmente bassi in Europa.
Rischi per la salute
L’assunzione prolungata di arsenico inorganico è stata associata a una serie di effetti nocivi sulla salute, tra cui alcune forme di cancro. Per la valutazione l’EFSA ha ritenuto l’aumento dell’incidenza di tumori della pelle associati all’esposizione all’arsenico inorganico quale effetto nocivo più rilevante. Gli esperti sono giunti alla conclusione che proteggersi dal cancro della
pelle può prevenire anche altri effetti potenzialmente nocivi.
Per valutare sostanze genotossiche e cancerogene presenti accidentalmente nella filiera alimentare, l’EFSA applica il calcolo del cosiddetto margine di esposizione (MOE) per i consumatori ossia il rapporto tra due fattori: il quantitativo al quale si osserva un effetto nocivo di piccola entità ma comunque misurabile e il livello di esposizione di una data popolazione alla sostanza in esame. Un MOE basso corrisponde a un rischio maggiore rispetto a un MOE alto.
Sulla base di dati tratti da studi sull’uomo, un MOE pari o inferiore a 1 corrisponderebbe a un livello di esposizione all’arsenico inorganico collegabile a un aumento del rischio di cancro della pelle. Negli adulti i MOE si attestano su valori bassi: essi variano tra 2 e 0,4 per i consumatori medi e tra 0,9 e 0,2 per i forti consumatori. Gli esperti hanno perciò concluso che ciò prospetta un problema per la salute.
Gli oceani sono spesso il punto di arrivo dei rifiuti di plastica che non sono stati fermati negli impianti di trattamento delle acque reflue; frammentati in piccole particelle, entrano nell’ecosistema marino e mettono a rischio tanto la fauna acquatica quanto la sicurezza della catena alimentare. Per questo motivo, i polimeri e gli additivi utilizzati nella produzione delle plastiche sono fra i contaminanti sempre più monitorati per le ricadute in termini di salute umana. Le microplastiche (MP) e le nanoplastiche (NP), polimeri plastici dell’ordine rispettivamente fra 0.1-5000 μm e <0,1 μm, sono oggetto di studi sempre più strutturati, perché sono numerosi i quesiti ancora aperti. Preoccupa oggi la loro diffusione nell’ambiente e in particolare nei bacini idrici e nel mare per l’interazione con l’ambiente acquatico (flora e fauna) e


per il pericolo che entrando nella catena alimentare arrivino nel nostro piatto. La dieta è infatti una delle principali fonti di esposizione a numerosi contaminanti, MP comprese.
Le MP rappresentano, insomma, una grave minaccia per la salute degli ecosistemi e quindi per la sicurezza alimentare. Il Mar Mediterraneo, bacino semi-chiuso densamente popolato e con elevato traffico marittimo, è particolarmente vulnerabile a questo tipo di inquinamento. È infatti una delle aree più colpite a livello globale. Qui, le particelle di plastica sono state trovate in acqua, ma anche nei sedimenti e negli organismi che lo abitano (Llorca et al.,
Francesca De Vecchi
Tecnologa alimentare OTALL e divulgatrice scientifica
2020). Tra l’altro i frammenti di plastica dispersi in mare, per il fatto che si presentano spesso di colori sgargianti, nonché per la loro galleggiabilità, divengono appetibili: sono, infatti, spesso scambiati come potenziali alimenti e quindi ingeriti.
Le MP identificate nelle ricerche fino ad oggi svolte nei pesci del Mediterraneo appartengono principalmente a due categorie:
§ frammenti di plastica: provengono da oggetti di plastica più grandi che si frammentano nel tempo;
§ fibre tessili: derivano principalmente da abiti e tessuti sintetici (il 35% di tutte le MP a livello globale si

Le microplastiche rilevate nei muscoli degli animali molto probabilmente sono state ingerite dai pesci e poi sono traslocate dall’apparato gastro-intestinale ai tessuti circostanti
origina dal lavaggio degli indumenti in fibra sintetica).
Oltre alla quantità, è importante analizzare la qualità dei residui di MP per valutare i potenziali rischi per la salute dei pesci e degli esseri umani. Una delle caratteristiche delle MP ingerite dai pesci è quella di accumularsi nei loro tessuti, causando danni fisici e alterazioni del sistema immunitario. MP sono state rilevate in diversi organismi marini, tra cui pesci, zooplancton, bivalvi, tartarughe, uccelli marini, capodogli e altri animali. Diversi studi che risalgono a oltre una decina di anni fa lo hanno riportato (De Stephanis et al., 2013; Eriksson e Burton, 2003; Wright et al., 2013; Cole et al., 2013; Farrell e Nelson, 2013). Le prime rilevazioni si sono concentrate sull’apparato digestivo, ma successivamente MP hanno cominciato a essere rilevate nei tessuti di muscoli e fegati (Abbasi et al., 2018). Negli animali ac-
quatici le MP ingerite provocano occlusione dopo l’ingestione; rilasciano gli additivi e i monomeri di cui sono composte; possono veicolare microrganismi patogeni ma anche inquinanti organici persistenti idrofobici e metalli pesanti assorbiti sulla loro superficie, che rappresentando un’ulteriore via di esposizione ad azione tossica per la fauna marina.
Il pericolo è poi quello del bioaccumulo nella catena trofica, che rende i pesci predatori e i grandi mammiferi acquatici più suscettibili rispetto a quelli più in basso nella catena alimentare. Dal danno biologico per gli animali al rischio di esposizione per la salute umana, il nesso è evidente (Journal of Sea research, 2023). Le microplastiche sono dunque un serio problema ambientale che sta colpendo gli ecosistemi marini in tutto il mondo, soprattutto quello mediterraneo e le ricadute interessano anche la filiera alimentare.
Una ricerca pubblicata sul Journal of Sea Research e condotta dall’Istituto Zooprofilattico Sperimentale di Teramo in collaborazione con il Croatian Veterinary Institute di Spalato e l’Università Politecnica delle Marche (con il supporto finanziario dell’Unione Nazionale Cooperative Italiane, UNCI) si è concentrata sul livello di contaminazione da microplastiche in due specie di pesce comuni nel Mediterraneo: il pesce spada ( Xiphias gladius ), pescato nel Mare Ionio, e il tonno rosso ( Thunnus thynnus ), proveniente dall’Adriatico, con la particolarità che sono state usate metodologie mai applicate prima nei muscoli dei pesci, quindi, nella parte che effettivamente viene consumata (“Detection of microplastics, polymers and additives in edible muscle of
swordfish (xiphias gladius) and bluefin tuna (thunnus thynnus) caught in the mediterranean sea” di Giacinto et al., 2023). Lo scopo è stato quello di quantificare in cinque esemplari di pesce spada e cinque di tonno le MP, il polietilene tereftalato (PET), il policarbonato (PC), il bisfenolo A (BPA) e l’acido ptalico (PTA) nel muscolo edibile degli esemplari catturati nel Mar Mediterraneo. Molti studi precedenti, secondo Federica Di Giacinto , ricercatrice del Centro per la Biologia delle acque dell’IZS Teramo, avevano valutato la presenza di MP solo nell’apparato digerente. Questo lavoro invece ha potuto evidenziare la contaminazione a livello muscolare non solo da microplastiche, ma anche da polimeri e additivi usati per la produzione di plastiche in generale.
Nel 2020 nel mondo sono state prodotte 53 milioni di tonnellate di fibre PET (EMR, 2022a), copolimero di PTA o dimethyl terephthalate (DMT) con glicole etilenico. Invece, la produzione di PC è limitata (4,6 milioni di tonnellate nel 2020) (EMR, 2022b). È un polimero termoplastico ad alte prestazioni, resistente, amorfo e trasparente, con densità
“Le microplastiche che abbiamo rilevato nei muscoli”, ha dichiarato la ricercatrice, “molto probabilmente sono state ingerite dai pesci e poi sono traslocate dall’apparato gastro-intestinale ai tessuti circostanti”. Anche se non è noto ancora il meccanismo in base al quale avviene il trasferimento, si è abbastanza sicuri che un fattore determinante sia la misura inferiore a 10 μm (per valori superiori non c’è passaggio). Mediante stereomicroscopia e microspettroscopia Raman
media di 1,2 g/cm3 con una quantità tipica di additivi rappresentativi, tra cui ritardanti di fiamma e stabilizzanti ultravioletti (rispettivamente 0,7-25% p/p e 0,05-3% p/p). La sicurezza del PC è stata messa sotto esame in quanto è prodotto mediante polimerizzazione per condensazione del monomero BPA (OMS, 2022).
si sono caratterizzate le microplastiche di dimensioni inferiori ai 10 μm estratte dai muscoli; mentre PET e PC, oltre a pigmenti e agli additivi BPA e PTA sono stati determinati via cromatografia liquida con spettrometria di massa. Alcune di queste sostanze, ampiamente utilizzate per la produzione di beni di plastica di largo consumo, sono da tempo sotto osservazione per valutarne gli effetti sulla salute (per esempio, il BPA è considerato un interferente endocrino).

La quantità di MP (dimensioni 1.2-10 μm) nei campioni analizzati era compresa fra 140 e 270 per chilogrammo nel pesce spada e da 160 a 270 nel tonno. Il polimero più rappresentato era il polipropilene nel pesce spada (33%) e nel tonno (34,7%), mentre i pigmenti più riscontrati sono stati PB115, PB116, PBr101/102. BPA è stato rilevato unicamente in un campione di ciascuna specie, mentre PC è stato trovato in 8 campioni; in tutti e 10 i campioni sono stati rilevati PTA e PET. Dall’analisi dei dati le due specie presentavano una contaminazione simile in termini di MP, PET, PC, BPA e PTA. Ma non è stata trovata correlazione fra PET, PC, BPA, PTA e MP. Entrando ancora più nel dettaglio, si è visto che la concentrazione di PET e il suo monomero PTA in entrambe le specie non rivelava alcuna significativa correlazione. Nessuna correlazione anche fra BPA –trovato solo in un campione per specie –e il suo polimero di provenienza PC, così come fra la concentrazione di BPA e MP (Figura 1).
In sostanza i due pesci presentavano un livello simile di contaminazione da plastica, con differenze invece per quanto concerne la morfologia dei frammenti, i colori, i pigmenti e i polimeri (Figura 2). I dati, conclude lo studio, suggeriscono che una parte dei monomeri trovati all’interno del pesce provenisse da fonti diverse rispetto alle MP presenti nel muscolo - erano cioè plastificanti e plastiche precedentemente decomposti – e che il tonno sia più a contatto con la contaminazione costiera mentre il pesce spada con un tipo di contaminazione d’altura, più dipendente dalla catena trofica. “Il lavoro in questione”, afferma Di Giacinto, “punta a contribuire a una conoscenza più approfondita di queste particolari categorie di inquinanti, sia dal punto di vista dell’estensione del feno-
BSwordfish
ND
PV C
PV Ac
PU
PS
PP
PL
PEV A
PE T
PE
Tuna
ND
PV C
PV Ac
PU
PS
PP
PL
PE Total
PEV A
PE T
meno, sia applicando nuove metodologie per la loro quantificazione”. “I prossimi passi saranno di valutare quale sia il livello di contaminazione in ulteriori animali acquatici, arrivando a una valutazione dell’effettiva esposizione alla quale sono esposti i consumatori”, ha concluso la ricercatrice.
Detection of microplastics, polymers and additives in edible muscle of swordfish (xiphias gladius) and bluefin tuna (thunnus thynnus) caught in the mediterranean sea. Di Giacinto et al., 2023. Detection of microplastics, polymers and additives in edible muscle of swordfish (Xiphias gladius) and bluefin tuna (Thunnus thynnus) caught in the Mediterranean Sea. Journal of Sea Research, 192, p.102359. https://doi.org/10.1016/j.seares.2023.102359
Non solo contaminanti emergenti. Il pesce è monitorato anche per la concentrazione di altre sostanze: i farmaci veterinari e i contaminanti chimiche di origine ambientale come mercurio, diossine e furani, policlorobifenili (PCB) e idrocarburi policiclici aromatici (IPA); che rientrano nel Piano Nazionale Residui, che, fino al 2022, ha comportato il prelievo di campioni mirati; un extrapiano predisposto nei casi di specifiche esigenze nazionali o locali e infine un campionamento su Sospetto, nei casi in cui ci sia motivo di sospettare la presenza di residui. Secondo i risultati dell’attività dell’ultimo Piano Nazionale Residui, nel 2022 sono stati prelevati in Italia 30.237 campioni, di cui:
§ 28.427 campioni sono stati prelevati nell’ambito del Piano mirato;
§ 1.125 nell’ambito delle attività di Extrapiano regionale;
§ 685 campioni su Sospetto.
Sui campioni sono stati eseguiti un totale di 473.146 controlli analitici per la ricerca di sostanze vietate e non autorizzate (49.1%) (gruppo A), medicinali autorizzati e contaminanti (62.8 %) (gruppo B). I campioni irregolari per la presenza di residui, nell’ambito del Piano mirato, sono stati complessivamente 19, pari allo 0.07 % del totale dei campioni prelevati, tutti di provenienza italiana, su cui sono state
riscontrate 20 sostanze responsabili delle non conformità. L’andamento è in linea con il trend degli ultimi anni con percentuali di irregolarità che si posizionano in generale a valori più bassi rispetto a quelli riscontrati in ambito comunitario.
L’acquacoltura si è rivelata fra i due settori col maggior numero di campioni non conformi (Figura 3).
Su 634 campioni di acquacoltura le non conformità, rilevate tutte nel muscolo di trota, sono imputabili in 6 casi alla presenza di coloranti (gruppo B3e) e in un caso a sostanze antibatteriche (B1, Trimethoprim), tutte a seguito di trattamenti illegali. Nel piano di controlli su Sospetto, che ha contato 685 prelievi, 4 campioni (su 11) hanno
riguardato ancora muscolo di trota non conforme sempre per trattamento illegale con Trimethoprim (in un caso dovuto a contaminazione accidentale).


Si tratta di dispositivi adatti a campionare superfici di ogni genere e ampiezza, punti difficilmente raggiungibili, attrezzature, carcasse animali, allevamenti ecc.
Vengono inumiditi con una soluzione sterile, spesso neutralizzante rispetto ai comuni disinfettanti, e poi strisciati sulla superficie delimitata da una cornice sterile di 10x10 cm o 5x5 cm. Infine vengono processati per seminare specifici terreni di coltura e determinare il numero di UFC.


Vuoi abbreviare i tempi?
Sono disponibili anche kit rapidi per la ricerca di microrganismi patogeni.


DEGLI ALIMENTI CXC 1-1969
Il Codex Alimentarius è un insieme di standard internazionali per gli alimenti, le bevande e gli ingredienti alimentari, sviluppato congiuntamente dall’Organizzazione Mondiale della Sanità (OMS) e dall’Organizzazione delle Nazioni Unite per l’Alimentazione e l’Agricoltura (FAO). Questo corpus normativo ha lo scopo di proteggere la salute dei consumatori e garantire pratiche commerciali eque nel settore alimentare su scala globale.
UN
Il termine “Codex Alimentarius” ha radici latine e significa letteralmente “libro degli alimenti”. Il suo sviluppo ha avuto inizio negli Anni ’60, con l’obiettivo di fornire linee guida armonizzate per garantire la sicurezza e la qualità degli alimenti a livello internazionale. Dal momento della sua creazione, il Codex ha subito revisioni e aggiornamenti costanti per riflettere gli sviluppi scientifici e tecnologici nel campo della sicurezza alimentare che a valle sono stati recepiti dall’HACCP.


Tra gli altri comitati coinvolti nello sviluppo e nell’aggiornamento dell’HACCP possiamo citare: National Advisory Committee on Microbiological Criteria for Foods (NACMCF), International Commission on Microbiological Specifications for Food (ICMSF) e International Life Sciences Institute (ILSI). In Europa vige il Regolamento UE 852/2004 il cui obiettivo principale è garantire un elevato livello di protezione dei consumatori in materia di sicurezza alimentare. L’articolo 5 del Regolamento 852 richiede l’attuazione dei principi HACCP, ma non richiede un sistema HACCP pienamente documentato. Il regolamento si applica a tutte le operazioni alimentari, a eccezione della produzione primaria.
Le revisioni dei Principi Generali di igiene degli alimenti CXC 1-1969 del 2020 e del 2022 da parte del Codex Alimentarius hanno
Paolo Bersighelli
Business Developer Manager
Food sector, BSI
Roberto Mozzone

Biologo, auditor e tutor qualificato
FSSC 22000
rappresentato importanti pietre miliari nella continua evoluzione degli standard alimentari globali.
La revisione del 2020 ha affrontato una serie di tematiche cruciali nel contesto attuale della sicurezza alimentare. Uno degli aspetti più significativi di questa revisione è stata l’integrazione di nuove tecnologie e metodologie per l’analisi dei rischi alimentari. Nello specifico i cambiamenti sono apprezzabili nei seguenti punti:
§ ampliamento sezione definizioni;
§ riferimento all’utilizzo dell’albero decisionale;
§ rafforzamento sezione formazione e competenze;
§ inclusione nella sezione impegno della direzione della clausola sulla cultura della sicurezza alimentare;
§ nuovo requisito per identificazione del lotto e tracciabilità.

In Europa vige il Regolamento UE 852/2004 il cui obiettivo principale è garantire un elevato livello di protezione dei consumatori in materia di sicurezza alimentare
Questo ha consentito una maggiore precisione nelle valutazioni dei rischi e una migliore gestione delle problematiche sanitarie relative agli allergeni introducendo un nuovo codice di condotta (CXC 80-2020 Code of practice on food allergen management for food business operators). Inoltre, la revisione del 2020 ha posto particolare enfasi sulla trasparenza e sulla partecipazione delle parti interessate nel processo decisionale. Ciò ha permesso una maggiore inclusione di prospettive diverse e ha rafforzato la legittimità e l’accettazione degli standard stabiliti.
La revisione del 2022 (pubblicata nel 2023) ha visto ulteriori miglioramenti negli standard alimentari, con un focus particolare sulla sostenibilità ambientale e sull’etica nel settore alimentare. Si è dedicata attenzione alla riduzione degli sprechi alimentari e alla promozione di pratiche agricole e di produzione più sostenibili.
Viene ampliato l’approfondimento sulle buone prassi igieniche o GHP - Good Hygiene Practices (comunque già presente nella versione 2020) e inserito un nuovo albero delle decisioni per la valutazione delle fasi del processo e l’identificazione dei CCP - Punti cri-
tici di controllo. La nuova versione dell’albero ha infatti solo quattro domande mentre la versione precedente ne aveva cinque disposte con un ordine diverso. L’inizio del nuovo albero è più in linea con quello proposto dall’Istituto Campden BRI e offre l’opportunità di identificare, nella domanda Q1, se un pericolo significativo può essere gestito da un PRP. Questi controlli preventivi possono essere ancora necessari per la sicurezza alimentare, ma non soddisfano i criteri per un CCP. Per queste situazioni, l’albero decisionale del Codex modificato potrebbe essere più utile, perché permette di identificare anche misure di controllo diverse dai CCP, con un criterio che si avvicina a quanto già previsto da ISO 22000 e dalla normativa USA, predisposta da FDA, nel Title 21 cfr. 117.126. Inoltre, la revisione del 2022 ha affrontato in modo più dettagliato le questioni legate all’etichettatura alimentare, fornendo linee guida più chiare per garantire informazioni accurate e accessibili ai consumatori.
CONCLUSIONI
Il Codex Alimentarius rimane un pilastro fondamentale nel panorama della sicurezza alimentare globale. Le revisioni del 2020 e del 2022 hanno dimostrato l’impegno continuo delle organizzazioni internazionali nel migliorare costantemente gli standard alimentari, garantendo la protezione della salute dei consumatori e promuovendo pratiche sostenibili nell’industria alimentare.
L’importanza dei Programmi di Prerequisito (GMP e GHP) come procedure necessarie a creare un ambiente di lavoro sicuro è stata rimarcata nella Linea guida del Codex, come anche la necessità di individuare altre misure di controllo, diverse dai CCP, al fine di controllare pericoli significati come quelli derivati dalle procedure di gestione degli allergeni, delle pulizie, dell’etichettatura e approvazione dei fornitori.
In un mondo in rapida evoluzione, la collaborazione internazionale e l’adattamento costante sono essenziali per affrontare sfide sempre nuove nel settore alimentare. Il Codex Alimentarius continua a svolgere un ruolo chiave in questo processo, fungendo da guida affidabile per produttori, consumatori e regolatori in tutto il mondo.
A COLLOQUIO CON MONICA PIN, TECNOLOGO ALIMENTARE, COORDINATRICE CONTROLLO QUALITÀ & HACCP MAGAZZINI
DI ECORNATURASÌ AL VERTICE NELLE PRODUZIONI BIOLOGICHE E BIODINAMICHE
ASan Vendemiano, provincia di Treviso, sorge EcorNaturaSì, la principale azienda italiana di distribuzione di prodotti biodinamici e biologici con 500 negozi serviti e oltre 300 aziende agricole impegnate nella produzione. Il marchio si occupa del commercio e della distribuzione all’ingrosso e al dettaglio attraverso un modello circolare, che parte dal seme e arriva alla tavola, in cui i diversi attori collaborano per dare vita a un flusso di relazioni responsabili, virtuose, etiche e rivolte al futuro. Il sito principale di stoccaggio, di recente costruzione, è un ce.di. multi-temperatura per poter andare incontro alle caratteristiche dei diversi prodotti, mantenendo idonee moda-


lità di conservazione (ortofrutticoli, freschi e anche prodotti secchi alcuni dei quali sono temperatura-dipendenti, ad esempio cioccolate e semiconserve). Il centro operativo si trova nell’area Interporto Bologna e comprende un sito di circa 48.200 mq, di cui 3.000 mq di superficie commerciale e uffici e 45.200 mq circa di superficie deposito logistico. Il magazzino è operativo dal 2017 e nel 2020, in piena pandemia, è stato ampliato: il blocco iniziale era di 40 mila metri di superficie calpestabile a cui si sono aggiunti 9 mila metri nel 2020. In questo contesto, decisamente proiettato alla sostenibilità ambientale, la sicurezza e l’igiene sono costantemente monitorati nel magazzino e lungo l’intero percorso di
Maurizio Pedrini Giornalista
distribuzione di prodotti altamente delicati. Abbiamo incontrato Monica Pin, Tecnologo Alimentare, coordinatrice Controllo qualità & HACCP Magazzini, per conoscere da vicino come è organizzato il sistema che garantisce non solo la massima salubrità dei prodotti offerti ai consumatori ma anche ottimali condizioni di lavoro al personale.
Presentiamo anzitutto la sua attività, riferita soprattutto al controllo qualità: che mansioni esercita in seno all’azienda? La mia figura di Tecnologo Alimentare come coordinatrice del Controllo Qualità è fondamentale per le ampie conoscenze che l’azienda richiede avendo una gam-

È basilare assicurare il mantenimento degli standard qualitativi e igienico-sanitari dei prodotti in particolare attraverso il rispetto della catena del freddo
Laureata magistrale in Scienze e Tecnologie Alimentari presso l’Università di Udine con voto 110/110 e iscritta all’albo dei Tecnologi Alimentari del Veneto e Trentino-Alto Adige. Ha collaborato diversi anni con l’Università di Udine per un progetto di sviluppo di una filiera per la produzione di frumento biologico di qualità e valorizzazione dei prodotti derivati e con una ditta di consulenza su igiene e sicurezza alimentare per la ristorazione
e la vendita al dettaglio. Successivamente ha iniziato il suo percorso lavorativo presso l’azienda EcorNaturaSì come addetta al controllo qualità. Da diversi anni ricopre la posizione di Responsabile del controllo qualità, coordinando un team di persone dislocato nei siti di stoccaggio merce dell’azienda, il cui scopo è monitorare e garantire che i prodotti siano conformi agli alti standard igienico sanitari, organolettici e biologici prefissati.

La formazione svolge un ruolo
fondamentale nel promuovere una cultura della pulizia
ma di più di 14.000 prodotti che spazia dall’ortofrutta agli alimenti confezionati, frigoconservati, materie prime, cosmesi e cura casa. Operando nel mercato come distributori, la sfida nel nostro lavoro è avere – su tutte le categorie merceologiche – la consapevolezza e la competenza dei fattori di pericolo igienico-sanitario associati all’alimento da diverse prospettive: in funzione del tipo di materie prime utilizzate, del tipo di confezionamento, delle specifiche caratteristiche chimico-fisiche microbiologiche del prodotto finito, delle modalità d’impiego e di conservazione, della destinazione d’uso e delle caratteristiche tecniche del processo produttivo.
Il suo delicato ruolo comporta notevoli responsabilità in termini di sicurezza: come lo vive nel quotidiano?
Nel rispetto delle leggi vigenti e della sostenibilità dei processi produttivi e distributivi, la mia funzione richiede di essere costantemente aggiornata sui cambiamenti normativi, legislativi, giuridici, scientifici, tecnologici e produttivi in atto per poter garantire la qualità e la sicurezza degli alimenti che il Gruppo commercializza. La continua collaborazione e comunicazione con i fornitori assicura ai consumatori un controllo costante dei processi e della qualità dei prodotti. In particolar modo per i prodotti private label, implementiamo strategie in accordo con i produttori per ottenere prodotti con alti standard qualitativi e contemporaneamente ridurre l’impatto ambientale promuovendo l’equità sociale e assicurando una gestione responsabile delle risorse. Ad esempio, collaboriamo nell’ideazione di ricettazioni
che siano adatte per soddisfare le nostre esigenze sia dal punto di vista nutrizionale-organolettico che etico-ambientale. Dove possibile riduciamo la quantità di plastica utilizzata negli imballaggi adottando soluzioni compostabili o riciclabili.
In particolare, quali sono i suoi specifici compiti nell’ambito del delicato sistema di controlli previsti dall’HACCP?
Il nostro obiettivo è sempre quello di assicurare la conformità dei prodotti immessi nel mercato: proprio per questo operiamo con un approccio di tipo preventivo attraverso un piano assiduo di monitoraggio analitico, legale e organolettico. Oltre a questo, il mio lavoro consiste anche nel redigere e aggiornare i manuali HACCP dei vari siti di stoccaggio per applicazione delle misure di corretta prassi operativa in materia di igiene e per l’implementazione dei prerequisiti. Da questo segue la predisposizione e l’attuazione delle procedure specifiche basate sui principi del sistema HACCP: è fondamentale attuare le procedure necessarie per controllare le condizioni operative dello stabilimento, garantendo il rispetto dei requisiti generali di igiene e sicurezza.
Quanto è importante per EcorNaturaSì il tema dell’igiene e quali sono i problemi che dovete affrontare?
È senz’altro un tema che ci sta particolarmente a cuore. Essendo EcornaturaSì distributore all’ingrosso di prodotti biologici e biodinamici, è inoltre basilare assicurare il mantenimento degli standard qualitativi e igienico-sanitari dei prodotti in particolare attraverso il rispetto della catena del freddo (cold chain), ovvero la garanzia di una temperatura costante dallo stabilimento di produzione fino al punto vendita attraverso tutte le fasi della supply chain. Per garantire una corretta gestione della catena del freddo e ottenere risultati con-
sistenti e persistenti nel tempo, la logistica di EcorNaturaSì – attraverso anche solide collaborazioni con partner terzi – coordina e monitora tutta la filiera dal ritiro della merce dai fornitori fino alla consegna presso i punti vendita.
Un nodo assai delicato nell’ottica dell’economia circolare è quello della gestione dei rifiuti, con quali soluzioni organizzative lo state affrontando?
La consegna ai nostri punti vendita, per lo più piccole realtà, è frequente e avviene utilizzando contenitori adiabatici con vuoto a rendere. Tali contenitori, grazie all’utilizzo del ghiaccio secco, sono in grado di consentire il mantenimento della catena del freddo anche con l’utilizzo di mezzi di trasporto non refrigerati, ma sempre con mezzi aventi caratteristiche tecnico-costruttive idonee per il trasporto in regime di freddo. A ogni reso, i contenitori sono controllati e sanificati prima del loro riutilizzo. Periodicamente vengono eseguiti dei tamponi di controllo per monitorare l’efficacia del trattamento di sanificazione attraverso l’utilizzo di un luminometro che valuta il livello di contaminazione. Il 90% delle nostre spedizioni avviene attraverso supporti riutilizzabili: oltre ai contenitori adiabatici, i roller per la merce stabile a temperatura ambiente e cassette con sponda ripiegabile (polymer) per l’ortofrutta. Anche questi dispositivi, a ogni rientro in sede, sono controllati, igienizzati e restituiti ai nostri produttori per essere riutilizzati lungo tutta la filiera, dal campo al negozio.
Quanto è sentito dalla vostra azienda il rischio di infestanti e quali sono le principali criticità?
Nella nostra attività, i prerequisiti riguardano: pulizia e disinfezione (GHP), manutenzione delle strutture e degli impianti, controllo degli animali infestanti, gestio-
ne dei rifiuti, formazione del personale. Mantenere un alto standard di pulizia nelle industrie alimentari è fondamentale per garantire la sicurezza e la qualità degli alimenti. Mantenere in buono stato di pulizia i locali e le attrezzature è considerata la principale misura atta a prevenire infestazioni da animali e insetti attirati all’interno del magazzino; alcuni insetti e animali potrebbero venire in contatto e contaminare anche alimenti preconfezionati, forando le confezioni con il loro apparato masticatorio. Per prevenire queste situazioni sono state implementate delle procedure che comportano una regolare e accurata pulizia delle varie aree dedicate allo stoccaggio con delle particolarità legate alla tipologia di prodotto. Un esempio in questo senso è la gestione della zona dedicata agli sfarinati che essendo biologici, sono più soggetti all’insorgenza di infestazioni perché non sono trattati. Sulla base del principio di prevenzione, questa zona è stata studiata per facilitare la rimozione di residui dovuti a rotture o perdite delle confezioni, terreno fertile per un’eventuale infestazione. I bancali di merce sono posizionati su scaffalature rialzate da terra: questo permette una facile individuazione delle polveri e l’aspirazione quotidiana per ovviare ad accumuli, specialmente nei punti di intersezione delle scaffalature e dei paracolpi. Il rialzo dei bancali è una gestione non adottata da tutte le aziende in una logica di ottimizzazione degli spazi ma nella nostra realtà biologica e dalla storicità, questa procedura è un punto fondamentale per il pest control. In generale, la frequenza delle pulizie dipende dalla natura della zona, dell’attrezzatura e delle referenze depositate. Nel comparto ortofrutta, la sanificazione delle aree ha un impatto maggiore, ad esempio, per il clima umido dell’ambiente, per lo stoccaggio delle verdure in foglia o per i residui di terra che gli ortofrutticoli possono avere.
Nel sito di stoccaggio è stato implementato un idoneo sistema di monitoraggio degli infestanti delle derrate con una ditta specializzata nel pest management. Il controllo qualità, in collaborazione con questo soggetto, ha la funzione di monitorare settimanalmente l’andamento della situazione e di individuare eventuali situazioni critiche con implementazione di attività specifiche: dal controllo del prodotto al blocco della merce, al ritiro dal mercato dei prodotti stessi in caso di sviluppo di infestazioni, etc. Le ispezioni regolari e il rispetto dei protocolli igienici sono fondamentali. Infatti, si è creata una sinergia tra l’ufficio qualità e l’ufficio sicurezza & facility management per assicurare un quotidiano monitoraggio delle attività svolte e per identificare le scelte più corrette per la nostra azienda in tema di attrezzature e prodotti per le pulizie. Oltre alla conformità agli standard normativi e all’efficacia ed efficienza del personale, si cerca di porre particolare attenzione all’impatto ambientale. Ogni semestre lo stato di pulizia e manutenzione della struttura è valutato attraverso una verifica ispettiva interna (audit): questo strumento costituisce la forma di validazione del Piano di pulizia e di verifica dell’attuazione del Piano di autocontrollo. In caso di risultati insoddisfacenti, il responsabile dell’attività è consultato per motivare il riscontro non positivo e comunicare le eventuali azioni correttive che intende adottare.
Il fattore umano, specialmente se adeguatamente formato e sensibilizzato, ha un ruolo fondamentale nel promuovere in azienda una vera cultura della pulizia: alla luce della sua esperienza, condivide questa considerazione?
Certamente, perché il personale che si occupa di operations può influire notevolmente sulla qualità del processo operativo, sia assicurando il rispetto delle procedure che evitando di contaminare il prodotto con comportamenti non adeguati. La formazione svolge un ruolo fondamentale nel promuovere una cultura della pulizia, sottolineando l’importanza di un’adeguata igiene al fine di mantenere un ambiente sicuro e igienico per gli operatori e per gli alimenti. La gestione dei ce.di. è affidata a un mix di dipendenti diretti e provider terzi, con personale specializzato, che operano rispetto al nostro piano di pulizie e sanificazione, alle nostre esigenze a livello etico ambientale e alla nostra sorveglianza. Questo si verifica sia per le attività di movimentazione logistica che le specifiche attività di pulizia. Le attrezzature utilizzate sono di ultima generazione e all’avanguardia.
Quali obiettivi vi siete dati per migliorare la sicurezza e le condizioni di lavoro del personale e rendere più efficiente, anche sotto il profilo tecnologico e organizzativo, l’attività all’interno dell’azienda?
Il centro operativo di Interporto è un magazzino innovativo che tenta di rispondere alle sfide continue della logistica. Per migliorare le condizioni di lavoro e al tempo stesso raggiungere nuovi standard in termini di efficacia, efficienza e qualità delle operazioni logistiche, è stato deciso di sviluppare un impianto di automazione logistica sviluppato su più aree del magazzino. Il sistema d’automazione logistica è il filo conduttore attorno al quale è stato progettato e realizzato il building. Si punta sull’automazione per migliorare le condizioni di lavoro attraverso: riduzione dei tempi di esposizione a basse temperature, riduzione dei pesi giornalieri da movimentare, creazione di postazioni sempre più ergonomiche per operazioni
manuali. L’automazione porta inoltre a un beneficio in termini di efficienza del processo logistico: maggiori capacità di stoccaggio, maggiore produttività, riduzione della possibilità di errore, tracciabilità dei prodotti più puntuale. Quella dei frigocon-
EcorNaturaSì SpA società benefit è l’azienda di riferimento nel settore biologico e biodinamico in Italia da quasi 40 anni. L’ecosistema aziendale si compone di una rete di 300 aziende agricole biologiche e biodinamiche, 315 negozi a insegna NaturaSì, presenti su tutto il territorio nazionale, e 1.334 collaboratori. L’azienda nasce nel 2009 dalla fusione di Ecor, il maggior distributore all’ingrosso di prodotti biologici e biodinamici nel comparto specializzato, e NaturaSì, il brand dei supermercati bio. EcorNaturasì favorisce lo sviluppo dell’agricoltura biologica, intesa come metodo agricolo che nutre il terreno, che tutela l’ambiente e la biodiversità, e che assicura lavoro anche ai piccoli produttori offrendo prodotti sani e di qualità per il benessere dell’uomo. EcorNaturaSì si occupa del commercio e della distribuzione all’ingrosso e al dettaglio attraverso un modello circolare, che parte dal seme e arriva alla tavola, in cui i diversi attori collaborano per dare vita a un flusso di relazioni responsabili, virtuose, etiche e rivolte al futuro. Fare economia in maniera efficace significa creare un sistema organico vivente, che non produca valore per uno a scapito degli altri. Per favorire questo processo evolutivo in modo da aumentare la resilienza dell’azienda e garantirne la sostenibilità economica massimizzando beneficio sociale e ambientale, l’azienda
servati (salumi e latticini gestiti a 4°C) è l’area a maggiore automazione perché si è scelto di ridurre il più possibile il tempo di esposizione degli operatori alle basse temperature. Per la parte delle referenze stabili a temperatura ambiente, abbiamo un sistema automatizzato per una parte, per lo più scatolame alto vendente.
L’efficienza raggiunta con l’automazione ha permesso sia di avere maggiore precisione in questa gestione sia di convertire
ore uomo in altre attività a più alto valore. La grande sfida che pone, e impone, un sistema di automazione logistica è quello di trovare modelli applicativi che possano portare efficienza nell’utilizzo della tecnologia, una forte interazione con i processi che restano in toto delegati all’operatore e grande attenzione per le situazioni ibride, ovvero dove è forte il connubio tra uomo e tecnologia, nel pieno spirito della filosofia del 4.0.

ha individuato un team di lavoro che si occupa in modo specifico di responsabilità sociale d’impresa che ha il compito di contribuire ad armonizzare i percorsi di sostenibilità nei processi aziendali. Alle 300 aziende del proprio ecosistema viene rivolta particolare attenzione perché si prendano cura dell’ambiente naturale. La ricerca della più alta qualità del prodotto, la trasparenza nei confronti di tutti gli attori della filiera, l’attenzione ai risvolti etici del proprio lavoro e la sostenibilità ambientale sono i valori di EcorNaturaSì, che guidano l’attività quotidiana di ogni settore dell’azienda. La cer-
tificazione biologica è di fondamentale importanza, perché le radici dell’azienda nascono nel 1985 in un piccolo negozio di prodotti biologici locali, coltivati da alcuni agricoltori della zona che abbracciano una filosofia per una alimentazione sana: tutti i prodotti vengono coltivati nel pieno rispetto della terra, della natura, dell’ambiente e quindi dell’uomo Le radici sono state fondamentali per preservare l’identità dell’azienda che è cresciuta e si è evoluta nel tempo contribuendo a definire la cultura aziendale sviluppatasi dalla visione e dalla mission dei fondatori.
La verifica dell’igiene ambientale è fondamentale per prevenire le infezioni in tutti gli ambiti ed è spesso eseguita con il bioluminometro. Si tratta di uno strumentino portatile che rileva in tempo reale il grado di pulizia delle superfici, molto utilizzato soprattutto per la velocità di test.
In particolare, il sistema Lumitester Smart di ultima generazione evidenzia la presenza di sostanza organica (ATP e suoi derivati) ed è di impiego molto semplice, garantendo un risultato affidabile, rapido e preciso. È utilizzabile per il controllo della sanificazione in tutti gli ambiti, come il farmaceutico, alimentare, sanitario, Ho.Re.Ca, industriale etc., offrendo la possibilità di effettuare un utile confronto sullo stato di igiene prima e dopo aver applicato le procedure di pulizia. Non richiede un training particolare. Il Lumitester Smart si utilizza in abbinamento con i tamponi Lucipac A3, con i quali si preleva il campione dalla superficie in esame. Dopo la lettura del tampone, pressoché istantanea, i risultati sono visualizzati sul display del Lumitester e memorizzati nell’archivio cloud a cui si può accedere in qualsiasi momento per un continuo monitoraggio dei dati. Il trasferimento dei risultati avviene in Bluetooth a smartphone, tablet e altri dispositivi.

KAIROS nell’antica Grecia era il dio del momento giusto, il corrispondente ellenico del nostro carpe diem: un’opportunità da cogliere. Per noi il momento giusto è arrivato nel 2005, quando abbiamo dato vita a un’azienda tutta al femminile in un contesto perfetto per le aziende del settore biomed. Trieste infatti è la città europea con il più alto nume-ro di ricercatori per abitanti e vanta una delle maggiori concentrazioni di

centri di ricer-ca e istituzioni scientifiche d’Italia.
SAFE, la seconda parte del nostro nome, significa “sicuro” e rappresenta l’elemento fondante del nostro impegno di fornire prodotti di qualità, soluzioni concrete e supporto tecnico personalizzato.
KAIROSAFE www.kairosafe.it

Maria Infusino, Silvana Cavella, Paolo Masi, Elena Torrieri Gruppo Scientifico Italiano di Confezionamento Alimentare (GSICA)
Dipartimento di Agraria, Università degli Studi di Napoli Federico II
Centro di Ateneo per l’Innovazione e lo Sviluppo dell’Industria Alimentare (CAISIAL), Università degli Studi di Napoli Federico I
Frutta e verdura sono costituenti essenziali della dieta quotidiana e negli ultimi anni il consumo di tali prodotti è aumentato costantemente. Tuttavia, tale categoria di alimenti è altamente deperibile, infatti è caratterizzata da una breve vita post-raccolta a causa dei danni meccanici, del deterioramento fisiologico e del decadimento microbiologico. Per l’elevata deperibilità, la frutta e la verdura contribuiscono in percentuale rilevante alla produzione di scarti alimentari, che rappresentano un’attuale preoccupazione globale urgente.
I pomodorini ciliegini, noti per il loro valore nutrizionale e il loro significativo segmento di mercato, sono frutti climaterici la cui shelf life è direttamente correlata alla velocità di respirazione (Sousa et al., 2017). I normali fenomeni
di senescenza portano a una graduale perdita delle tipiche proprietà di texture con conseguenze anche sull’aspetto del prodotto. Per garantire un’elevata qualità del prodotto durante la conservazione, la sua contaminazione iniziale deve essere quanto più bassa possibile e il sistema di confezionamento deve garantire nello spazio di testa una concentrazione ottimale di ossigeno (3-5%) (Volpe et al., 2023).
Recentemente è stata sviluppata una nuova tecnologia di conservazione che prevede l’uso di onde elettrostatiche generate da un campo elettrico a basso voltaggio. Commercialmente nota con il nome di DEMBA+, tale tecnologia, utilizzata in combinazione alla refrigerazione, consente di prolungare la shelf life di alimenti deperibili, come la frutta e la verdura, grazie alla vibrazione delle molecole di acqua presenti nelle cellule degli alimenti indotta dal campo elettromagnetico. Il dispositi-
vo può essere installato all’interno delle celle di refrigerazione e agisce anche sui prodotti confezionati con imballaggi trasparenti alle onde elettromagnetiche. Recentemente la tecnologia è stata applicata con risultati promettenti a fragole fresche (Yang et al., 2023).
Il presente lavoro riporta i risultati ottenuti nell’ambito di una sperimentazione svolta presso il Centro di Ateneo per l’Innovazione e lo Sviluppo dell’Industria Alimentare (CAISIAL) dell’Università di Napoli Federico II. L’obiettivo del lavoro è stato investigare la potenzialità della tecnologia DEMBA+ nel preservare la qualità del pomodorino ciliegino confezionato, durante la conservazione a 4°C.
I pomodori ciliegino sono stati acquistati presso un supermercato locale a Portici (NA) e trasportati in laboratorio in 30

minuti. Il prodotto dopo una preliminare cernita è stato confezionato con un film di naturflex in busta da 250 g. Il materiale di confezionamento e il peso del prodotto sono stati ottimizzati per ottenere all’equilibrio una concentrazione di ossigeno del 5% e di anidride carbonica del 10%. Successivamente, un lotto di prodotto è stato conservato in cella a 4°C in presenza del sistema DEMBA +, mentre il lotto controllo è stato conservato in cella a 4°C. I campioni sono stati conservati per 30 giorni e a differenti tempi di conservazione sono stati valutati i principali indicatori di qualità: calo peso, colore, turgidità, pH, solidi solubili, acidità, contenuto di polifenoli totali e capacità antiossidante.
PRINCIPALI RISULTATI
Nel corso della conservazione, i pomodorini ciliegino controllo mostrano un graduale calo peso che raggiunge percentuali del 18% dopo 30 giorni di conservazione. I campioni conservati in presenza del dispositivo DEMBA+ mostrano valori significativamente inferiori di calo peso che assume un valore pari al 13% dopo 30 giorni di conservazione. Il calo peso del prodotto dipende dalla differenza tra la sua attività dell’acqua e l’umidità relativa dell’ambiente di conservazione. Considerando che le condizioni di conservazione e confezionamento sono simili, il

minor calo peso del prodotto può essere giustificato da una ridotta diffusione delle molecole di acqua grazie ai possibili moti vibrazionali indotti dalle onde elettromagnetiche. Le variazioni osservate nel calo peso hanno mostrato un effetto significativo sulle proprietà di texture del prodotto. In particolare, la forza necessaria a deformare il prodotto fino a rottura decresce in maniera esponenziale per i campioni controllo da un valore iniziale di 28 N fino a un valore medio di 16 N che rimane costante dopo 15 giorni di conservazione. I campioni conservati con il sistema DEMBA+ mostrano invece una graduale diminuzione di tale parametro che raggiunge il valore di 18 N dopo 30 giorni di conservazione (Figura 1). Inoltre, il minor calo peso determina un più basso livello di raggrinzimento della buccia e, quindi, un limitato peggioramento dell’aspetto visivo del prodotto nel corso della conservazione (Figura 2). Il sistema DEMBA +, invece, non ha effetti significativi sulla variazione del colore, del pH, dei solidi solubili e dell’acidità titolabile. Inoltre, il contenuto di polifenoli totali dei pomodorini conservati in presenza del sistema DEMBA + ha mostrato valori significativamente maggiori rispetto ai campioni controllo nel corso della conservazione. Tali differenze non hanno però messo in evidenza differenze in termini di capacità antiossidante.
I risultati del lavoro mettono evidenziano che il sistema DEMBA+ i è una tecnica efficace nel preservare la qualità del pomodorino ciliegino nel corso della conservazione a 4°C. Ulteriori studi sono necessari per confermare le ipotesi sul meccanismo di azione a carico delle molecole di acqua del prodotto.
§ Sousa, A.R., Oliveira, J.C., Sousa-Gallagher, M.J., 2017. Determination of the respiration rate parameters of cherry tomatoes and their joint confidence regions using closed systems. Journal of Food Engineering, 206, 13-22
§ Volpe, S., Giello, M., Cavella, S., Masi, P., Villani, F., Torrieri, E. (2023). Effect of Plasma Activated Water and Sodium Caseinate Based Coating on the Quality of Minimally Processed Cherry Tomatoes during Storage. Chemical Engineering Transactions, vol 102, 2023
§ Yang, N., Zhang, X., Lu, Y., Jiang, F., Yu, J., Sun, X., &Hao, Y. (2023). Use DENBA+ to assist refrigeration and extend the shelf-life of strawberry fruit. Postharvest Biology and Technology, 195, 112152
Figura 1. Variazione della forza a rottura in funzione del tempo di conservazione di pomodorini ciliegino confezionati con un film di naturflex e conservati a 4°C per 30 giorni. Campione controllo (n) campione DEMBA + () Figura 2. Campioni di pomodorino ciliegino dopo 30 giorni di conservazione a 4°C. (A) campione controllo; (B) Campione DEMBA+
Stefania Milanello Esperta in impianti alimentari e divulgatrice scientifica
COME IN TUTTI I SETTORI, ANCHE IN QUELLO AGROALIMENTARE, LE TECNOLOGIE DIGITALI GIOCANO UN RUOLO CHIAVE, OFFRENDO NUMEROSI VANTAGGI, TRA CUI MAGGIORE EFFICIENZA, MIGLIORE QUALITÀ E SICUREZZA DEI PRODOTTI, RIDUZIONE DEGLI SPRECHI E MAGGIORE SOSTENIBILITÀ AMBIENTALE
Per migliorare la produzione agricola e la qualità dei prodotti e per soddisfare le richieste del mercato di una popolazione in continua crescita, l’industria agroalimentare deve sviluppare soluzioni innovative e sostenibili. Come in tutti i settori, anche in quello agroalimentare, la tecnologia gioca un ruolo chiave. Con la crescente domanda di cibo, l’industria agroalimentare deve produrre di più con meno risorse, affrontando al tempo stesso problemi di sostenibilità. Le tecnologie digitali, come l’Internet delle cose, l’intelligenza artificiale, la blockchain e la robotica, stanno trasformando il modo in cui il cibo viene prodotto, lavorato e distribuito. Esse offrono numerosi vantaggi, tra cui maggiore efficienza, migliore qualità e sicurezza dei
prodotti, riduzione degli sprechi e sostenibilità ambientale. Le tecnologie digitali consentono il monitoraggio in tempo reale di parametri critici, come temperatura, pH e umidità, che possono aiutare a prevenire il deterioramento, ridurre gli sprechi alimentari e garantire che alimenti sicuri e di alta qualità raggiungano i consumatori. Il settore agroalimentare sta attraversando una rivoluzione digitale. I computer sono ormai utilizzati in tutti i processi legati all’agricoltura, dai macchinari ai sistemi decisionali, attraverso l’uso di robot, sensori e tecnologie di sistemi cyber-fisici. Utilizzando sistemi integrati di supporto alle decisioni in combinazione con reti e servizi Internet avanzati, il settore agroalimentare ha un grande potenziale per un miglioramento radicale in termini di intel-
ligenza, efficienza, sostenibilità e prestazioni.
L’uso delle tecnologie digitali, come l’Internet delle cose (IoT), i Big Data, l’intelligenza artificiale (AI) e le tecnologie blockchain, offrono nuove opportunità per affrontare le sfide del settore. Esse stanno cambiando il modo in cui le aziende fanno affari, poiché influenzano le routine operative e creano nuove modalità di networking con clienti, fornitori e stakeholder.
Si tratta di strumenti, sistemi, dispositivi e risorse elettronici in grado di generare, archiviare o elaborare dati. Ciò include applicazioni software, dispositivi hardware e reti di comunicazione che consentono l’elaborazione, l’archiviazione e il trasfe-

rimento dei dati. In agricoltura, termini come “agricoltura digitale”, “agricoltura 4.0” e “rivoluzione agricola digitale” vengono utilizzati per descrivere un approccio volto a rendere più efficiente la produzione alimentare. Questa efficienza è ottenuta attraverso la comunicazione semplificata di dati di alta qualità e l’uso delle tecnologie attuali. L’ottimizzazione dei sistemi alimentari può raggiungere obiettivi sociali, ambientali ed economici, come l’aumento dei rendimenti produttivi, il miglioramento della qualità nutrizionale dei prodotti alimentari, una maggiore trasparenza, un miglioramento del benessere degli animali e una produzione più verde. Alcuni strumenti digitali aumentano l’efficienza agronomica/produttiva, altri impat-
tano sulle catene del valore, compresa la tecnologia dell’e-commerce. Essa, infatti, migliora l’accesso al mercato e collega direttamente consumatori e produttori. Tuttavia, presenta anche sfide, come la crescente concentrazione del potere di mercato nelle mani di poche piattaforme selezionate.
Esistono diversi tipi di tecnologie digitali utilizzati nella trasformazione agroalimentare, come l’intelligenza artificiale, l’Internet delle cose, la blockchain, i Big Data, la robotica e i sensori intelligenti. Gli obiettivi riguardano il miglioramento della produttività, la riduzione dei rischi per la sicurezza alimentare e il miglioramento della sostenibilità dell’intera catena di approvvigionamento.
L’intelligenza artificiale si riferisce alla capacità delle macchine di acquisire conoscenze e prendere decisioni informate elaborando dati. Comprende un insieme di tecnologie basate su dispositivi elettronici, sistemi informatici e robot che potenziano e migliorano l’acutezza, la velocità, la precisione e l’efficienza dell’attività dell’utente. L’obiettivo principale dell’intelligenza artificiale è rendere computer, macchine o robot intelligenti, simili al pensiero umano. Nel regno della tecnologia, l’intelligenza artificiale dovrebbe essere in grado di identificare facilmente le cose, riconoscere oggetti, analizzare profili, trovare soluzioni, prendere decisioni, ordinare azioni, prevedere anomalie e apprendere e ricor-
L’ottimizzazione dei sistemi può aumentare i rendimenti produttivi,
migliorare la qualità nutrizionale dei prodotti, garantire una maggiore trasparenza, migliorare il benessere degli animali e rendere la produzione più verdeLe tecnologie digitali consentono il monitoraggio in tempo reale di parametri critici, come temperatura, pH e umidità, che possono aiutare a prevenire il deterioramento, ridurre gli sprechi alimentari e garantire che alimenti sicuri e di alta qualità raggiungano i consumatori

dare i passaggi successivi nella catena di approvvigionamento. Nella trasformazione agroalimentare, l’intelligenza artificiale può essere utilizzata per automatizzare attività come lo smistamento, la classificazione e il confezionamento dei prodotti, prevedendo le rese dei raccolti e rilevando i rischi per la sicurezza alimentare. Può anche essere impiegata per mitigare i fattori di rischio, migliorare la sicurezza alimentare e raggiungere l’autosufficienza, riducendo al contempo la povertà, minimizzando la fame e preservando le risorse naturali. Le tecnologie emergenti basate sull’intelligenza artificiale possono contribuire ad aumentare la produttività e l’efficienza nella catena di approvvigionamento alimentare, migliorando al contempo l’agricoltura e preservando la biodiversità.
L’IoT si riferisce all’integrazione di sensori e attuatori all’interno di oggetti fisici,
consentendo la loro connessione tramite reti cablate e wireless, spesso utilizzando lo stesso protocollo Internet utilizzato da Internet. Nel 2021, il mercato dell’IoT ammontava a 385 miliardi di dollari e si prevede che raggiungerà oltre 2,4 trilioni di dollari entro il 2029 (Insights, 2021). Il concetto è quello di connettere dispositivi e sensori a Internet per raccogliere dati e automatizzare i processi. L’integrazione delle piattaforme IoT in agricoltura, nota anche come “agricoltura di precisione” o “agricoltura intelligente”, fornisce ulteriori fonti di dati che descrivono caratteristiche agricole, come acqua, suolo, esseri umani e animali, con più dati. L’integrazione delle piattaforme IoT nelle pratiche agricole presenta notevoli sfide di ricerca, in particolare per quanto riguarda l’interoperabilità dell’archiviazione e dell’utilizzo dei dati nel cloud (protocolli, sicurezza, etc.), il monitoraggio delle prestazioni, etc. Inoltre, l’utente finale deve partecipare a
sessioni di formazione per apprendere e comprendere l’uso e l’applicabilità della tecnologia. La maggior parte delle applicazioni IoT delle tecnologie digitali nel settore agroalimentare si concentrano sul monitoraggio della temperatura, sulla tracciabilità, sull’umidità, sul colore e sul miglioramento delle prestazioni di sostenibilità. Applicazioni di questa natura rivestono una notevole importanza all’interno della filiera vegetale, in particolare durante la fase agricola, che richiede un monitoraggio preciso degli indicatori per migliorare la produttività delle colture. I sistemi IoT si sono rivelati determinanti nell’ottimizzazione dei parametri operativi, compresi l’utilizzo di pesticidi e acqua. Altri parametri possono essere monitorati tramite IoT, come composizione del suolo, umidità, temperatura e fisiologia delle colture, che possono fornire informazioni per un monitoraggio più accurato delle colture.
Blockchain è una tecnologia che consente di registrare le transazioni e archiviare i dati in modo sicuro e decentralizzato. È stata sviluppata nel 2009 e l’applicazione di questa tecnologia nella filiera agroalimentare si è progressivamente estesa grazie ai suoi vantaggi nel garantire la tracciabilità, la trasparenza e la sicurezza degli alimenti.
BD si riferisce a dati di grandi dimensioni, in rapido movimento e complessi, che non possono essere elaborati e gestiti con tecniche convenzionali e tradizionali. Si applica a dati così vasti, diversificati e in rapida evoluzione che le tecnologie, gli strumenti e i sistemi convenzionali non sono in grado di gestirli in modo efficace. La tecnologia è caratterizzata dalle sue cinque “V” (volume, velocità, varietà, veridicità e valore), che si riferiscono ai grandi volumi di dati non strutturati a bassa densità, alla rapida velocità con cui i dati vengono ricevuti e sfruttati, alla varietà di disponibilità di molti tipi di dati, al livello di confidenza e qualità dei dati e, infine, all’individuazione dei valori sfruttati dal DB per supportare il processo decisionale. L’integrazione delle tecnologie BD nei progetti agroalimentari riveste un’importanza significativa in tre aree chiave: l’estensione dei dati degli agricoltori per generare nuova conoscenza, la creazione di servizi e processi innovativi da parte di fornitori IT e sviluppatori di software e l’estensione e l’adattamento di modelli BD legati alle ICT e alle Fabbriche del Futuro (FoF) per l’agricoltura. Attualmente esistono numerosi archivi di Big Data che garantiscono l’accessibilità e l’utilizzo dei dati agroalimentari. Ad esempio, le immagini satellitari e le informazioni metrologiche di Google e NASAEarth Exchange, i dati su suolo, acqua e geospaziali del National Resources Conservation Service (USA).
L’obiettivo dello sviluppo di modelli di conoscenza in agricoltura è quello di utilizzare diversi archivi di dati e trasformarli in servizi redditizi che aiutino i vari soggetti interessati nel processo decisionale. I temi di ricerca più recenti riguardano la raccolta e l’ingegneria precisa dei dati al servizio della creazione di conoscenza di nuovi modelli agricoli, dell’applicazione della tecnologia in agricoltura, dell’allocazione delle risorse, dei quadri di valutazione del rischio, della definizione delle politiche e della gestione della qualità. Inoltre, i ricercatori si stanno concentrando sulla qualificazione dei modelli decisionali e sull’identificazione di parametri decisionali quali regione, territorio, clima, pianta, tempo e processo.
Le tecnologie digitali hanno consentito a macchine e robot di svolgere compiti che in precedenza venivano svolti dagli esseri umani. L’automazione e la robotizzazione stanno guidando lo sviluppo dell’agricoltura intelligente e accelerando la transizione verso un’industria alimentare 4.0. Nella lavorazione agroalimentare, la robotica può automatizzare attività quali semina, piantagione, diserbo, raccolta, movimentazione, raccolta, taglio, affettamento e confezionamento, migliorando così l’efficienza e riducendo i costi di manodopera.
L’Industria 4.0 è un modo per garantire la domanda alimentare e la sicurezza alimentare, poiché integra tecnologie dell’informazione e della comunicazione come IoT, IoT industriale (IIoT), cobot, cloud computing, analisi dei big data, intelligenza artificiale (AI), digital twin (DT), blockchain, tecnologia di comunicazione di sesta generazione (6G) e machine le-
arning (ML). Queste possono essere utilizzate digitalmente per vari scopi, tra cui la raccolta, la trasmissione, l’elaborazione dei dati (come la visualizzazione dei fattori che influiscono sulla qualità degli alimenti e l’analisi degli sprechi alimentari), la gestione e l’analisi. La loro implementazione mira ad affrontare le sfide e ottimizzare le attività lungo tutta la filiera, migliorando così la sicurezza e la sostenibilità alimentare. Altri strumenti, come i software di tracciabilità e l’identificazione a radiofrequenza, hanno il potenziale per migliorare il sistema di tracciabilità degli alimenti. Le tecnologie digitali, come blockchain e RFID, possono tracciare il movimento dei prodotti lungo tutta la filiera, consentendo alle aziende di ottimizzare la logistica, ridurre gli sprechi e migliorare la tracciabilità e la trasparenza. Le tecnologie di automazione, come la robotica e l’intelligenza artificiale, possono migliorare l’efficienza e ridurre i costi della manodopera. Infine, le tecnologie digitali possono ottimizzare l’uso dell’energia negli impianti di trasformazione agroalimentare. Ad esempio, i sistemi di illuminazione e riscaldamento intelligenti possono regolare automaticamente il consumo di energia in base all’occupazione e alle condizioni meteorologiche, riducendo gli sprechi e i costi energetici.
IL FUTURO DELLE TECNOLOGIE DIGITALI
Le tecnologie digitali rappresentano un’opportunità di trasformazione per l’industria agroalimentare, offrendo vantaggi significativi in termini di efficienza, sicurezza alimentare, sostenibilità e trasparenza. La crescente integrazione di IoT, AI, blockchain e robotica nella lavorazione agroalimentare mostra implementazioni di successo e prefigura un futuro promettente. I costi, l’accessibilità tecnologica, le competenze tecniche e la resistenza al cambiamento sono le sfide da affrontare per il futuro di queste tecnologie nelle aziende alimentari.

Martina Halker
Esperta in impianti alimentari e divulgatrice scientifica
I SETTORI IN CUI L’INTELLIGENZA ARTIFICIALE PUÒ FARE LA DIFFERENZA SONO MOLTI: DALL’APPROVVIGIONAMENTO DI MATERIE PRIME ALL’AGRICOLTURA DI PRECISIONE, DALLE DIVERSE FASI PRODUTTIVE ALLA RINTRACCIABILITÀ, DALLA LOGISTICA IN TUTTE
FINO ALLA CATENA DISTRIBUTIVA
Il rapporto tra intelligenza artificiale e settore agroalimentare si fa sempre più stretto e riguarda diverse tematiche: il miglioramento della capacità produttiva, il minor consumo di risorse, la creazione di una agricoltura sempre più sostenibile, una maggiore sicurezza alimentare. Quando si parla di intelligenza artificiale si parla di dati in arrivo dal settore agricolo, dalla produzione, dalla logistica e dai trasporti, dal mondo della ricerca e della distribuzione, e di collegamento fra questi. L’utilizzo dell’intelligenza artificiale sta portando e porterà al settore agroalimentare un’innovazione basata sulla conoscenza sempre più precisa e focalizzata sulle diverse realtà produttive.
AI E AGRICOLTURA DI PRECISIONE
L’agricoltura di precisione è una realtà sempre più presente nel mondo agricolo italiano. Migliaia di dati riguardanti la mappatura dei terreni, combinati con
quelli delle previsioni metereologiche, dello storico dei raccolti precedenti, grazie all’intelligenza artificiale sono analizzati e forniscono informazioni preziose per una agricoltura adatta alle diverse condizioni ambientali e strutturali.
L’intelligenza artificiale, che combina reti neurali e un controllo predittivo basato sui dati, può essere utilizzata per migliorare l’efficienza energetica e ottimizzare la crescita delle colture, prevedere con precisione il clima interno di coltivazioni agricole in ambiente controllato e lo stato delle colture, sulla base di dati di controllo, inclusi quelli relativi a temperatura, umidità, CO2, irrigazione e fertilizzazione. Il controllo predittivo del modello basato sui dati utilizza tecniche di apprendimento automatico per tenere conto dei cambiamenti imprevedibili delle condizioni meteorologiche, per prendere le migliori decisioni. Lo studio “An AI framework integrating physics-informed
neural network with predictive control for energy-efficient food production in the built environment” (Guoqing Hu e Fengqi You, Applied Energy - Volume 348, 15 ottobre 2023) ha dimostrato l’efficacia di quadri di controllo basati sull’intelligenza artificiale nella coltivazione del pomodoro, anche in climi diversi come Ithaca (New York) e Tucson (Arizona). Con l’aiuto dell’intelligenza artificiale si riesce a mantenere l’ambiente di coltivazione ottimale per le colture, sfruttando l’approccio MPC (Model Predictive Control) e le informazioni sulle previsioni meteorologiche in caso di incertezze. Il rilevamento rapido degli agenti patogeni negli alimenti e nell’acqua utilizzata in agricoltura è essenziale per garantire la sicurezza alimentare e la salute pubblica. L’intelligenza artificiale può aiutare nel rilevamento accelerato e automatizzato di agenti patogeni in vari campioni di acqua utilizzata in agricoltura e negli alimenti. In

L’intelligenza artificiale può essere utilizzata
per migliorare l’efficienza energetica e ottimizzare la crescita delle colture
particolare possono essere utilizzati modelli di deep learning per identificare e quantificare i batteri bersaglio.
La scienza dei materiali alimentari si è evoluta per supportare lo sviluppo di nuovi prodotti alimentari, collegando le caratteristiche sensoriali del cibo, quelle nutrizionali, quelle tecnologiche. Tuttavia, il food design non si è evoluto così rapidamente per far fronte a questa crescente complessità dei sistemi alimentari. La capacità di comprendere, catturare l’attenzione e trasformare le richieste dei consumatori negli attributi chimici e fisici del prodotto finale rimane una delle maggiori sfide dell’industria alimentare. Di conseguenza, sono necessari nuovi modi per supportare il food design. Allo studio ci sono molte
applicazioni del food design che utilizzano l’intelligenza artificiale (AI)/reti generative profonde e il concetto di design inverso, come spiegato nell’articolo “Inverse design and AI/Deep generative networks in food design: A comprehensive review” (Mahmoud Al-Sarayreh, Mariza Gomes Reis, Alistar Carr, Marlon Martins dos Reis, Trends in Food Science & Technology - Volume 138, agosto 2023, pagine 215228). Proprio perché la progettazione e la formulazione degli alimenti implicano processi complessi e molteplici parametri di progettazione, l’intelligenza artificiale e le reti neurali possono essere di grande aiuto alle aziende alimentari. La maggior parte degli approcci si basano sull’associazione tra gli ingredienti, ma prestano meno attenzione alle proprietà funzionali. La rappresentazione dei dati rimane
la vera sfida e una lacuna da colmare per il raggiungimento di un concetto reale e applicabile di progettazione alimentare digitale. Mentre i metodi basati sul deep learning e sull’elaborazione del linguaggio naturale sono attualmente i più utilizzati, gli approcci generativi profondi rimangono un’area di ricerca critica.
Le filiere agroalimentari sono sempre più digitalizzate e automatizzate attraverso l’uso di tecnologie come l’Internet delle cose (IoT), la blockchain e l’intelligenza artificiale (AI). Tali sforzi di digitalizzazione spesso si basano sul cloud computing, che crea sovraccarico di larghezza di banda, elevata latenza, problemi di sicurezza e privacy. Lo studio “Chapter Nine: Blockchain meets edge-AI for food supply

alimentare e per condurre i calcoli necessari sullo smartphone.
AI E INDIVIDUAZIONE DEGLI ALLERGENI
Sebbene molte persone soffrano di sensibilità e intolleranze alimentari, le allergie alimentari colpiscono solo circa il 5-10% della popolazione totale, ma le loro conseguenze possono essere gravi o addirittura fatali. La gestione delle allergie e delle intolleranze alimentari si basa sull’evitare gli ingredienti e i prodotti alimentari che le causano e, quindi, le persone colpite devono adottare uno stile di vita di costante vigilanza. Per evitare la loro ingestione accidentale, in molti paesi sono state implementate normative sull’etichettatura degli allergeni, come il Food Allergen Labeling and Consumer Protection Act (FALCPA) del 2004 negli Stati Uniti o il Regolamento (UE) 1169/2011 “relativo alla fornitura di informazioni sugli alimenti ai consumatori”
nell’Unione Europea. I metodi attuali per rilevare gli allergeni alimentari (test immunologici, approcci basati sulla spettrometria di massa, metodi basati sugli acidi nucleici e biosensori) possono essere implementati solo in laboratori professionali altamente attrezzati e, sebbene siano oggi disponibili alcuni kit commerciali portatili per il rilevamento orientato al consumatore, il loro utilizzo spesso richiede istruzioni dettagliate, un’attenta manipolazione e preparazione dei campioni, reagenti chimici, costosi materiali non riutilizzabili e rilevatori/lettori specializzati. Gli approcci di deep learning potrebbero rappresentare un’alternativa innovativa ai classici metodi di rilevamento degli allergeni. Gli algoritmi di deep learning sono stati impiegati con successo per rilevare e quantificare diversi adulteranti nelle cariossidi e nelle farine di riso, nel caffè macinato o latte in polvere, anche a livello di tracce.
Per fare ciò, le immagini digitali di prodotti autentici e adulterati vengono acquisite e analizzate utilizzando reti neurali convoluzionali (CNN) per costruire modelli che ne consentano la discriminazione. Questa tecnologia sarebbe particolarmente interessante per i consumatori allergici perché può essere implementata con un semplice smartphone. La tecnica si basa sull’analisi di fotografie scattate con una semplice macchina fotografica reflex e sulla successiva classificazione in gruppi assegnati al tipo e alla quantità di adulterante. Sono molti gli studi che provano come l’imaging digitale, combinata con tecniche di deep learning, possa essere utilizzata per il rilevamento degli allergeni alimentari.
Le tecniche di intelligenza artificiale si sono evolute in strumenti pratici, rapidi
ed efficaci in combinazione con dispositivi per la valutazione della qualità, in particolare nel rilevamento di adulterazioni e difetti dei prodotti agricoli. I risultati ottenuti dai sensori richiedono l’applicazione di tecniche di intelligenza artificiale caso-specifiche volte a migliorare la comprensione del set di dati, nonché la classificazione e la previsione. L’abbinamento dell’AI e dei sensori si sta mostrando promettente nel rilevamento di adulterazioni e dei difetti di prodotti alimentari e agricoli, con una precisione che, in alcuni casi arriva anche al 100%. Le applicazioni devono ancora essere migliorate. Per questo è necessario perseguire e convalidare potenziali sviluppi futuri, nuovi sensori e algoritmi di deep learning, ma anche il monitoraggio in tempo reale e la modellazione predittiva potrebbero aiutare a evitare problemi di qualità prima che si verifichino, ridurre il rischio di frode e garantire prodotti di alto valore. L’intelligenza artificiale consente l’identificazione non distruttiva di adulterazioni che potrebbero non essere rilevabili dall’ispezione umana o dai metodi di laboratorio convenzionali. Inoltre, può essere un modo efficiente ed economicamente vantaggioso per ricercare possibili adulteranti in grandi quantità di prodotti in breve tempo. La capacità dell’intelligenza artificiale di apprendere e adattarsi dai nuovi dati può migliorare la sua precisione nel tempo.
Le reti neurali artificiali (ANN), l’apprendimento profondo (DL), la logica fuzzy (FL), la Support Vector Machine (SVM) e il Random Forest (RF) possono essere utilizzati per la valutazione rapida della qualità dei prodotti alimentari. Le reti neurali convoluzionali (CNN) sono uno dei metodi principali per apprendere le caratteristiche delle informazioni digitali in ingresso e la loro classificazione. La Support Vector Machine (SVM) viene spesso applicata a problemi di classificazione nei settori agricolo e alimentare. A differenza delle ANN,

le SVM hanno il vantaggio di essere meno inclini al sovradattamento. Inoltre, sono molto efficaci anche con dati di grandi dimensioni. Recentemente, la SVM è stata utilizzata per valutare la qualità di prodotti alimentari e agricoli, adulterazioni nel formaggio, nel cetriolo di mare, nel pomodoro, nel mirtillo, nella carne lavorata. Un sistema formato da un microscopico digitale 3D e dalle CNN è stato utilizzato per rilevare la farina di pesce adulterata. È stato sviluppato un modello CNN di classificazione qualitativa e previsione quantitativa per l’adulterazione della carne di montone con carne di maiale o anatra. Altri ricercatori hanno utilizzato una telecamera termografica combinata alle CNN per classificare il miele puro e i campioni di miele adulterato.
Random Forest (RF), multilayer perceptron (MLP) e gradient boosting machine (GBM) sono utilizzati come tecniche di
intelligenza artificiale per rilevare frodi nei prodotti lattiero-caseari, attraverso l’aggiunta di siero di latte, amido, formaldeide e urea, in base alle proprietà termofisiche determinate utilizzando la calorimetria differenziale a scansione (DSC). Sulla base delle caratteristiche spettrali dell’infusione del tè, è stato sviluppato un modello di previsione per il rilevamento rapido del carminio, un colorante sintetico, nel tè nero, utilizzando le rete neurale Multi-Layer Perceptron (MLP). Inoltre, gli MLP combinati con la spettroscopia di fluorescenza sono anche in grado di distinguere l’olio extra vergine di oliva fresco (EVOO) dai campioni contaminati che contengono EVOO scaduto. Altri studi si stanno focalizzando sull’integrazione dell’intelligenza artificiale con il naso elettronico, come approcci non invasivi per il rilevamento dell’adulterazione dello zafferano.

Stefania Milanello
Esperta in impianti alimentari e divulgatrice scientifica
GLI UTILIZZI SONO MOLTEPLICI: PREVISIONE DI FATTI FUTURI A PARTIRE DA UNO STORICO, DETERMINAZIONE DEL GRADO DI MATURAZIONE DI FRUTTA E VERDURA, LETTURA DI CODICE A BARRE “SPORCHI”, AGRICOLTURA DI PRECISIONE, TECNICHE DI VISIONE ARTIFICIALE, AGV, CLASSIFICAZIONE DI ALIMENTI, TRACCIABILITÀ DELLA QUALITÀ E TEMPERATURA DEGLI ALIMENTI DURANTE IL TRASPORTO
Le reti neurali (ANN - Artificial Neural Network o, più semplicemente, NN - Neural Network) sono modelli matematici costituiti da neuroni artificiali che, nell’intento di replicarlo artificialmente, ricalcano il funzionamento del cervello umano, per raggiungere prestazioni cognitive il più simili possibili. Le applicazioni delle reti neurali riguardano l’elettronica, l’ingegneria, il controllo di veicoli e processi, la previsione, l’elaborazione di dati, analisi predittiva e molto altro ancora. Il funzionamento delle reti neurali prevede unità computazionali elementari o neuroni artificiali facenti parte di una rete più ampia con elevate capacità di elaborazione dei dati. Le reti neurali sono strettamente correlate al Deep Learning o apprendimento profondo, che si basa su algoritmi capaci di imitare la struttura neuronale del cervello umano. Queste reti neurali sono organizzate in modo da processare
le informazioni per strati: uno di ingresso, uno, chiamato hidden, nascosto, e quello di uscita. Il primo strato riceve i dati che arrivano dall’esterno; il secondo li elabora e l’ultimo adatta i dati elaborati per il successivo livello della rete neurale. Funziona tutto a cascata: ciò che esce dal primo livello funge da informazione per il primo strato del secondo livello e così via. Parlando di reti neurali si fa spesso riferimento al Machine Learning, ovvero una branca dell’intelligenza artificiale grazie alla quale i sistemi vengono addestrati fino a identificare modelli e prendere decisioni autonomamente.
Le reti neurali possono essere utilizzate dalle aziende alimentari ad esempio per prevedere il futuro a partire da uno storico, per individuare anomalie o per prevedere le risposte dei clienti al lancio di
un nuovo prodotto o di una campagna pubblicitaria-marketing, proprio perché capaci di identificare e analizzare relazioni complesse tra una molteplicità di dati, anche non lineari. Quando ad esempio compriamo qualcosa online o scegliamo un film o una canzone, ci arrivano dei suggerimenti basati su quello che le reti neurali prevedono che potrebbe essere di nostro gradimento. L’analisi predittiva è in grado di ridurre i guasti imprevisti delle linee produttive, contribuendo a diminuire i costi di manutenzione e i fermo impianto imprevisti.
Altre applicazioni pratiche delle reti neurali riguardano la possibilità di determinare il grado di maturazione di frutta e verdura, monitorando i cambiamenti dei pigmenti, grazie all’utilizzo di un sensore di luce visibile capace di catturare dati spettrali accurati. Questi sono comparati con un data base di dati rilevati da diversi prodotti ortofrutticoli a più stadi di

L’analisi predittiva è in grado di ridurre i guasti imprevisti delle linee produttive, contribuendo a diminuire i costi di manutenzione e i fermo impianto imprevisti
maturazione, selezionando quelli maturi da quelli che ancora non lo sono.
Le reti neurali possono aiutare a leggere i codice a barre “sporchi”, ovvero non perfettamente leggibili perché sfuocati, ruotati, con grinze ecc. Anche in questo caso occorre addestrare le reti neurali con una serie di campioni da cui prendere spunto. L’algoritmo elabora le informazioni, minimizza le interferenze di lettura, aumentando l’accuratezza rispetto agli strumenti tradizionali.
Le reti neurali servono anche la Smart Agriculture o agricoltura di precisione, per gestire in modo intelligente le attività agricole, ad esempio grazie alla predizione di patologie sulle piante, al riconoscimento e alla classificazione delle stesse, in modo da ridurre l’utilizzo di
pesticidi e i consumi di acqua e migliorare la qualità dei prodotti stessi. L’utilizzo di sensori wi-fi, sul posto o sui droni consente di raccogliere i dati per poi essere elaborati da algoritmi di Deep Learning, incrociandoli, ad esempio, anche con le previsioni meteo. I dati processati possono essere utilizzati per prevedere eventuali problematiche, come la bassa o l’elevata umidità del terreno, la presenza di insetti, la quantità di sostanze presenti nel terreno, come i sali minerali, per intervenire al meglio e limitare le perdite. Una mappatura del livello di umidità del terreno consente un’irrigazione di precisione e un minore consumo di acqua. L’analisi dei dati potrebbe restringersi anche al singolo filare o alla singola pianta o frutto ed essere sfrutta-
ta per il riconoscimento di insorgenze di patologie o infestazioni. È possibile non solo individuare una contaminazione, ma anche classificare i livelli di rischio. L’agricoltura di precisione interessa anche la sostenibilità ambientale: risparmio di risorse idriche, meno sprechi, meno fertilizzanti e insetticidi - pesticidi e numero di interventi sulle colture, consentono di ridurre la carbon footprint dei prodotti, il loro impatto idrologico e chimico sul terreno. Il vantaggio non sarà solo ambientale, ma anche di immagine aziendale, grazie a valori di sostenibilità sempre più apprezzati e premiati dai consumatori.
Allo stesso modo nel settore food & beverage le reti neurali e il deep learning possono essere utilizzati per l’identifica-
Le reti neurali e il deep learning possono essere utilizzati lungo la linea di produzione
per l’identificazione dei contaminanti e dei difetti

Le reti neurali possono aiutare a leggere i codice a barre “sporchi”, ovvero non perfettamente leggibili perché sfuocati,
Anche in questo caso occorre addestrare le reti neurali con una serie di campioni da cui prendere spunto
zione dei contaminanti e dei difetti lungo la linea di produzione. Gli stessi detector a raggi X possono diventare più precisi e individuare i difetti in tempo reale, escludendo il prodotto non conforme, grazie all’addestramento delle reti neurali.
Altra applicazione riguarda la tracciabilità di filiera e la tutela di prodotti Made in Italy, DOP, IGP etc. o anche il riconoscimento di contaminazioni alimentari, ad esempio da insetti.
Gli AGV (automatic guided vehicle) sono robot automatizzati che trasportano la merce tra due punti del magazzino senza un conduttore, attraverso un circuito prestabilito, riducendo i tempi di movimentazione dei carichi. In questo ambito le reti neurali e il deep learning servono a misurare le prestazioni e il comportamento degli AGV, raccoglie informazioni sulla localizzazione, sul traffico, sull’utilizzo giornaliero e sull’interferenza di
ostacoli, quali persone, carrelli elevatori in movimento, altri veicoli, al fine di migliorare il sistema, configurarlo e sfruttarlo al meglio.
Su Food and Humanity (1 agosto 2023) è stato pubblicato uno studio dal titolo “A comparative study of deep learning methods for food classification with images” di Geeristico Suddul, Jean Fabrice, Laurent Seguin, che affronta l’aspetto dell’identificazione e della classificazione degli alimenti utilizzando l’intelligenza artificiale (AI) attraverso tecniche di visione artificiale, apprendimento profondo e trasferimento di apprendimento. In particolare, sono state testate diverse tecniche di visione artificiale basate sull’apprendimento automatico per il rilevamento degli alimenti dalle imma-
gini, per individuare le più efficienti. Gli obiettivi sono stati in primo luogo identificare un dataset appropriato di immagini alimentari, poi valutare l’efficacia dei modelli di deep learning costruiti da zero e, infine, utilizzare il transfer learning applicando modelli con parametri preappresi. Allo scopo è stato utilizzato un dataset contenente oltre 16000 immagini di alimenti, classificate in 11 categorie: pane, latticini, dessert, uova, cibo fritto, carne, tagliatelle/pasta, riso, frutti di mare, zuppa e verdura/frutta. Sono state generate computazionalmente altre 15884 immagini per ciascun esperimento, con tecniche di aumento dei dati come rotazione, spostamento, taglio, zoom e capovolgimento. Gli esperimenti con diverse reti neurali convoluzionali (CNN) dimostrano che l’apprendimento del trasferimento con il modello EfficientNetV2 ha raggiunto una precisio-
ne di validazione significativa del 94,5% nella classificazione dei diversi tipi di alimenti dalle immagini.
Il campo della visione artificiale si è evoluto ulteriormente, con maggiori risorse informatiche, set di dati più grandi e reti neurali convoluzionali più avanzate. Questi miglioramenti possono contribuire ad aumentare ulteriormente la precisione della classificazione degli alimenti dalle immagini. Si arriverà a proporre il piatto più appropriato a una dieta specifica o a diverse condizioni di salute. La limitazione principale, attualmente, rimane il rilevamento e il riconoscimento dei diversi ingredienti in un piatto, dovuto all’indisponibilità di un’ampia varietà di set di dati di immagini di alimenti con etichette dettagliate. Il passo successivo è di utilizzare le reti neurali per l’identificazione dei nutrienti dalle immagini degli alimenti. Elencare gli ingredienti in ciascuna immagine raccolta può aiutare i modelli di deep learning a ottenere risultati migliori nella classificazione degli alimenti. Al momento, le rilevazioni numeriche non sono molto precise, ma in futuro le percentuali di errore si abbasseranno a valori accettabili. Gli studi si concentreranno sulla valutazione di come i modelli determinano le caratteristiche nelle immagini degli alimenti utilizzando la tecnica Gradient-weighted Class Activation Mapping (Grad-CAM), che consente di analizzare le reti addestrate, restituendo una mappa di probabilità.
E TEMPERATURA EFFETTIVA DEGLI ALIMENTI DURANTE IL TRASPORTO

model” di Noothi Manisha, Madiraju Jagadeeshwar, pubblicato su High-Confidence Computing lo scorso marzo, viene sviluppato un sistema di tracciabilità della qualità di prodotti lattiero-caseari che utilizza BC-Deep Residual Network (BC-DRN). Questo lavoro di ricerca si concentra principalmente sullo sviluppo di un sistema di tracciabilità della qualità alimentare utilizzando IoT, BC e Deep learning. La tecnica BC-DRN raccoglie i dati dai dispositivi IoT, che vengono poi convertiti in blocco dal BC.
La tracciabilità alimentare è un fattore critico che può garantire la sicurezza alimentare per aumentare la credibilità del prodotto, ottenendo così una maggiore soddisfazione e fidelizzazione degli utenti. Nello studio “BC driven IoTbased food quality traceability system for dairy product using deep learning
Lo studio “An improved artificial neural network using multi-source data to estimate food temperature during multi-temperature delivery” (Yifeng Zou, Junzhang Wu, Xinfang Wang, Kimberly Morales, Guanghai Liu e Alessandro Manzardo - Journal of Food Engineering, 2023) si è occupato invece di reti neurali utilizzate per stimare la temperatura de-
gli alimenti durante il trasporto in veicoli multitemperatura. Lo scopo è di evitare sprechi e perdite dovuti a una cattiva gestione delle temperature della catena del freddo per gli alimenti deperibili. Questo studio ha sviluppato un innovativo modello ANN per stimare le temperature in tempo reale dei prodotti alimentari nei veicoli per la consegna. Per stimare la temperatura del carico in tempo reale nei veicoli sono stati utilizzati sensori di temperatura wireless, fondamentali per una gestione efficace del controllo della temperatura mediante l’apprendimento automatico utilizzando l’ANN. Il modello ANN proposto tiene conto dei parametri chiave che influenzano la temperatura dei prodotti alimentari, quali la temperatura esterna, quella iniziale dell’alimento, il tasso di perdita termica dell’involucro del veicolo, il tempo di carico/scarico e il numero di fermate per tali operazioni etc.
Altre applicazioni pratiche delle reti neurali riguardano la possibilità di determinare il grado di maturazione di frutta e verdura, monitorando i cambiamenti dei pigmenti, grazie all’utilizzo di un sensore di luce visibile capace di catturare dati spettrali accurati VINCENZO BOZZETTI
VINCENZO BOZZETTI
Negli anni ’40 e ’50 del secolo scorso l’alimentazione – in generale – badava prima a riempire le pance vuote e, solo in un secondo tempo, alle parole. Negli anni ’60 e ’70 con la disponibilità delle forniture alimentari assicurate, si iniziò a parlare e discutere in merito alla qualità degli alimenti. Negli anni ’80 e ’90 le parole sulla sicurezza alimentare e le certificazioni divennero il “ritornello” quotidiano per operatori e consumatori. Negli anni 2000, con la pancia decisamente piena, gli alimenti divennero portatori di significati culturali, quindi, oltre che a nutrire, divennero simboli della qualità della vita.
Nel ventennio successivo, le varie diete alimentari, i differenti stili di vita, le evoluzioni dei pasti fuori casa, i percorsi culturali dei consumatori hanno contribuito in varia misura a creare quel complesso e articolato mosaico della domanda alimentare odierna, nella quale il produttore di alimenti deve ineluttabilmente cercare la sua giusta dimensione e il corretto posizionamento per le sue produzioni da offrire al mercato. In altre parole, mentre prima bastava offrire al mercato un alimento per trovare l’acquirente, oggi è necessario produrre l’alimento per una determinata fascia di consumatori e comunicarlo idoneamente. Ma come?
Comincia l’intrigante metamorfosi del cibo che diventa parola
Qui comincia l’intrigante metamorfosi del cibo che diventa parola, ovvero della parola che diventa cibo. Pensiamo per un attimo alle diverse situazioni: per esempio, laddove l’alimentazione significa solo nutrizione fisiologica; ma con l’alimentazione possono entrare in scena anche la valutazione e la narrazione soggettiva; diversamente descrizione e racconto possono utilizzare anche una terminologia oggettiva. Una situazione del tutto differente quando la narrazione diventa retorica, enfatica o fantasiosa e orientata alla palese persuasione! Indubbiamente un contesto trasversale, fluido, promiscuo, che attraversa diverse azioni come il mangiare, il giudicare, il raccontare, il descrivere, il narrare, l’affabulare e anche il modaiolo “food storytelling”, talvolta reale, talaltra emotivo e fantasioso. E tu lettore quale preferisci?
Volete dire la vostra? Scrivere a: redazione.food@quine.it

Bioagro offre una vasta gamma di starter per lavorazioni artigianali ed industriali di salumi, formaggi, prodotti da forno, vegetali fermentati e per la conservazione dei prodotti ittici. Lieviti enologici e muffe
Collaborazioni con molte tra le più importanti aziende agroalimentari italiane
Forte attenzione alle piccole produzioni locali
Colture “confezionate su misura” in esclusiva per i propri clienti
Consulenza tecnica nella scelta delle soluzioni produttive migliori
